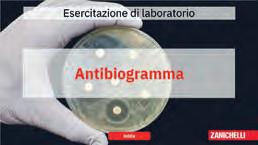
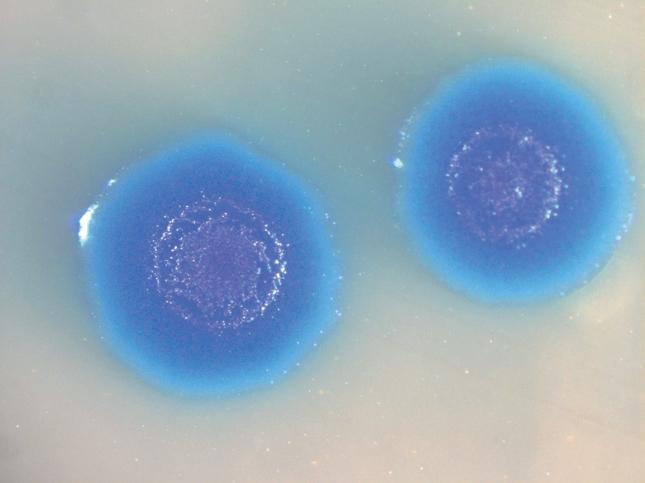

cura di Gianni Dehò Enrica Galli
Paolo Landini Marco Ventura


cura di Gianni Dehò Enrica Galli
Paolo Landini Marco Ventura

PARTE A Struttura e funzioni delle cellule procariote
Capitolo 1 Alla scoperta del mondo microbico
Capitolo 2 La cellula

PARTE B Crescita microbica e metabolismo
Capitolo 3 Nutrizione e crescita microbica
Capitolo 4 Metabolismo microbico
Capitolo 5 Energia dalle trasformazioni chimiche: chemiotrofia
Capitolo 6 Energia dalla luce: procarioti fototrofi
Capitolo 7 Assimilazione, biosintesi e cicli biogeochimici degli elementi

PARTE C Genetica batterica e biologia molecolare
Capitolo 8 Genoma dei procarioti
Capitolo 9 Trasmissione dell’informazione genetica
Capitolo 10 Plasticità del genoma batterico: trasferimento genico orizzontale
Capitolo 11 Trascrizione e traduzione
Capitolo 12 Regolazione dell’espressione genica
Capitolo 13 Divisione cellulare e differenziamento

PARTE D Eredità infettiva: i virus
Capitolo 14 Che cosa sono i virus
Capitolo 15 Batteriofagi, i virus dei batteri
Capitolo 16 I virus degli eucarioti

PARTE E Genomica e sistematica
Capitolo 17 Analisi globale delle cellule microbiche: le discipline omiche
Capitolo 18 Sistematica e filogenesi dei microrganismi

PARTE F Microrganismi in ambienti naturali e interazioni con altri organismi
Capitolo 19 Microbiologia ambientale ed ecologia microbica
Capitolo 20 Interazioni tra batteri: strategie di cooperazione e competizione
Capitolo 21 Interazioni dei microrganismi con gli organismi vegetali
Capitolo 22 Il microbiota
Capitolo 23 Interazioni con gli organismi animali: la patogenesi

PARTE G Meccanismi di difesa dell’ospite DISPONIBILE IN DIGITALE
Capitolo 24 Immunità innata
Capitolo 25 Immunità adattativa
Strumenti di lettura e digitali
Prefazioni
Autrici e autori

di Gianni Dehò ed Enrica Galli
1.1 Il mondo dei microrganismi
1.1.1 Cellula, organismo vivente, microrganismo
1.1.2 Limiti della crescita e riciclo della materia
1.1.3 Unità e diversità del mondo vivente
1.1.4 Procarioti-eucarioti, Bacteria-Archaea
1.1.5 Organismi modello e diversità microbica
1.2.2 Dalle molecole semplici alle strutture sopramolecolari
di carbonio
tappe significative nella storia della microbiologia 17
di Paola Quatrini, Alessandra Polissi, Anna Maria Puglia, Anna Maria Sanangelantoni ed Ezio Ricca
LA CELLULA
2.1 La cellula procariote [di Paola Quatrini] 20
2.1.1 Differenze e similitudini tra cellula procariote e cellula eucariote
2.1.2 Differenze e similitudini tra batteri e archei 21 2.1.3 Morfologia, dimensioni e organizzazione delle cellule procariote
2.1.4 Morfogenesi delle cellule batteriche
MEMBRANE E PARETI
2.2 Rivestimento delle cellule procariote [di Alessandra Polissi]
2.2.1
e struttura della membrana plasmatica nei batteri • Membrana plasmatica negli Archaea
2.2.2 Funzioni della membrana plasmatica
• Barriera selettiva • Produzione di energia • Trasduzione del segnale • Biosintesi di componenti cellulari
2.3 Parete batterica [di Paola Quatrini]
2.3.2 Peptidoglicano 36
2.3.3 Biosintesi del peptidoglicano e accrescimento della parete mureinica 37 • 1° stadio • 2° stadio • 3° stadio
2.3.4 Biogenesi della parete mureinica 48
2.3.5 Parete dei batteri Gram positivi 49
2.4 Parete dei batteri Gram negativi
[di Alessandra Polissi] 51
2.4.1 Periplasma 51
2.4.2 Membrana esterna: struttura, composizione e funzioni 52
2.4.3 Biogenesi della membrana esterna 54
2.4.4 Trasporto delle proteine integrali della membrana esterna 54
2.4.5 Trasporto delle lipoproteine 55
2.4.6 Trasporto del lipopolisaccaride 56
2.5 Altri tipi di parete nei Bacteria [di Paola Quatrini] 57
2.6 Parete cellulare negli Archaea
[di Anna Maria Sanangelantoni] 62
2.7 Capsula e altri rivestimenti esterni
[di Anna Maria Puglia] 63
2.7.1 Strato S 63
2.7.2 Capsule e polisaccaridi extracellulari 64
BIOGENESI DEI RIVESTIMENTI BATTERICI E SECREZIONE DI MACROMOLECOLE
[di Alessandra Polissi]
2.8 Sistema di secrezione Sec e sue diramazioni Sec-dipendenti 66
2.8.1 Indirizzamento delle proteine alla membrana interna 67
2.8.2 Indirizzamento delle proteine all’ambiente extracellulare 68 • Sistema di secrezione di tipo II • Sistema di secrezione a due partner • Sistema dell’autotrasporto (sistema di secrezione di tipo V) • Secrezione attraverso la via chaperon/usciere
2.9 Sistemi di secrezione indipendenti da Sec 71
2.9.1 Trasporto attraverso la membrana plasmatica di proteine ripiegate: il sistema Tat 71
2.9.2 Trasportatori ABC 71
2.9.3 Sistema di secrezione di tipo III 73
2.9.4 Sistema di secrezione di tipo IV 75
2.9.5 Sistema di secrezione di tipo VI 76
APPENDICI ESTERNE [di Anna Maria Puglia]
2.10 Flagelli 79
2.10.1
CITOPLASMA E SUOI COMPONENTI [di Paola Quatrini e Anna Maria Puglia]
• Induzione della sporulazione • Formazione del setto di divisione asimmetrico • Inglobamento della prespora • Formazione della corteccia • Formazione del rivestimento esterno • Maturazione e rilascio della spora • Germinazione
2.14.2 Struttura della spora 97
� Scheda 2.1 La colorazione di Gram 24
� Scheda 2.2 Monodermi e didermi 25
� Scheda 2.3 Antibiotici che agiscono sulle membrane [di Stefania Stefani e Margherita Sosio] 30
� Scheda 2.4 Antibiotici inibitori della sintesi del peptidoglicano [di Stefania Stefani e Margherita Sosio] 40
� Scheda 2.5 I batteri Gram positivi (monodermi) [di Anna Maria Sanangelantoni] 50
� Scheda 2.6 I micobatteri [di Anna Maria Sanangelantoni] 57
� Scheda 2.7 La colorazione di Ziehl-Neelsen (acidoresistenza) 59
� Scheda 2.8 Antibiotici antimicobatterici per il trattamento della tubercolosi [di Margherita Sosio] 59
� Scheda 2.9 I micoplasmi: batteri Gram positivi senza parete [di Anna Maria Sanangelantoni] 61
� Scheda 2.10 Le clamidie: batteri Gram negativi senza parete mureinica [di Anna Maria Sanangelantoni] 62
� Scheda 2.11 Le vescicole extracellulari 78
� Scheda 2.12 Differenziamento e sviluppo batterico 92
� Scheda 2.13 La colorazione delle spore (metodo di Schaeffer-Fulton o verde malachite) 94
� Scheda 2.14 Insetticidi e tossine entomopatogene di Bacillus thuringiensis
[di Anna Maria Sanangenlantoni ed Ezio Ricca] 97

Nutrizione e crescita
microbica 100
di Ezio Ricca, Loredana Baccigalupi, Stefania Stefani e Margherita Sosio
PRINCIPI DI NUTRIZIONE MICROBICA
[di Ezio Ricca e Loredana Baccigalupi]
3.1 Composizione elementare delle cellule 101
3.1.1 I sei elementi che costituiscono le macromolecole biologiche 101 • Carbonio • Ossigeno e idrogeno • Azoto • Fosforo • Zolfo • Selenio • Altri elementi
3.2 Categorie nutrizionali 105
3.2.1 Fattori di crescita: prototrofia e auxotrofia 106
3.3 Assimilazione dei nutrienti: trasporto di molecole dall’ambiente 106
3.3.1 Trasporto passivo 107
3.3.2 Trasporto attivo primario e secondario 108
3.3.3 Trasporto con traslocazione di gruppo 109
3.3.4 Idrolisi extracellulare di macromolecole e trasporto dei prodotti di degradazione 110
3.4 Terreni di coltura 110
3.4.1 Terreni minimi e complessi 110
3.4.2 Terreni solidi 111
3.4.3 Uso dei terreni solidi per l’isolamento di colture pure 112
3.4.4 Terreni arricchiti, selettivi e differenziali 114
CRESCITA DELLE POPOLAZIONI MICROBICHE
3.5 Come si determina la concentrazione di microrganismi in una coltura 116
3.5.1 Determinazione della biomassa: peso secco 116
3.5.2 Misurazione della torbidità di una coltura 116
3.5.3 Conta totale 117
3.5.4 Conta vitale 117
3.6 Analisi della crescita microbica 119
3.6.1 Descrizione matematica della crescita per divisione binaria 119
3.6.2 Rappresentazione grafica della crescita batterica 120
3.6.3 Analisi della curva di crescita di una popolazione microbica 120 • Fase di latenza • Fase di crescita esponenziale • Fase stazionaria • Fase di morte
3.6.4 Crescita diauxica 122
3.6.5 Crescita continua: il chemostato 123
3.7 Fattori che influenzano la crescita microbica
3.7.1 Temperatura
3.7.2 pH
3.7.3 Disponibilità di acqua 126 • Alofilia e alotolleranza
3.7.4 Disponibilità di ossigeno
3.7.5 Colture microbiche aerobie e anaerobie 129
3.7.6 Microrganismi “non (ancora) coltivabili” 130
CONTROLLO E INIBIZIONE DELLA CRESCITA
MICROBICA [di Ezio Ricca e Loredana Baccigalupi]
3.8 Metodi fisici
ANTIBIOTICI [di Stefania Stefani e Margherita Sosio]
3.10 Antibiotici 136
3.10.1 Effetti degli antibiotici sul microrganismo 136
3.10.2 Saggi di sensibilità agli antibiotici 138 • Metodo di diffusione in agar • Metodo delle diluizioni in brodo: stima della MIC
3.10.3 Spettro d’azione, tolleranza intrinseca e resistenza acquisita 139
3.10.4 Meccanismi d’azione dei principali antibiotici139
� Scheda 3.1 Descrizione matematica della crescita esponenziale 121
� Scheda 3.2 Il metabolismo secondario: ruolo fisiologico e interesse applicativo 137
� Scheda 3.3 Antibiotici: uso clinico e conseguenze ecologiche 142
Scheda Web 3.1 Vie biosintetiche dei metaboliti secondari
Scheda Web 3.2 Alla ricerca di nuove molecole bioattive da microrganismi
Metabolismo microbico
di Anna Maria Sanangelantoni e Davide Zannoni
4.1 Principali forme di energia utile nelle reazioni biologiche 145
4.1.1 Energia libera e potenziali di ossidoriduzione 145
4.2 Reazioni di ossidoriduzione biologica 147
4.2.1 Potenziali di riduzione 147
4.2.2 Scala dei potenziali redox 149
4.2.3 Trasportatori di elettroni 149
4.3 ATP e altri composti ad alta energia 152
4.4 Sintesi di ATP 152
4.4.1 Fosforilazione a livello del substrato 152
4.4.2 Fosforilazione a livello di membrana 153
• Catena di trasporto di elettroni dei batteri chemioeterotrofi
• Catena di trasporto di elettroni nella fotofosforilazione
4.5 ATP sintasi e sintesi di ATP a livello di membrana 156
Scheda Web 4.1 Lo stato di ossidazione di un elemento
Scheda Web 4.2 Energia libera di Gibbs e calcolo del potenziale elettrico
Scheda Web 4.3 Pirofosfati e polifosfati per la produzione di ATP
chimiche: chemiotrofia 157
di Anna Maria Sanangelantoni e Davide Zannoni
ENERGIA DALLA DEGRADAZIONE DI SOSTANZE
ORGANICHE: I BATTERI CHEMIORGANOTROFI
5.1 Metabolismo fermentativo 159
5.1.1 Degradazione del glucosio ad acido piruvico 160
• Glicolisi • Via di Entner-Doudoroff
• Ossidazione del glucosio attraverso la via del pentoso fosfato • Riossidazione del NADH e riduzione del piruvato
5.1.2 Fermentazione lattica 162
• Fermentazione omolattica
• Fermentazione eterolattica
• Fermentazione dei bifidobatteri
5.1.3 Fermentazione alcolica (lieviti e batteri) 167
5.1.4 Fermentazione acido-mista e 2,3-butandiolica degli enterobatteri 169
5.1.5 Fermentazione propionica 173
5.1.6 Fermentazione butirrica e acetonbutanolica dei clostridi e altre fermentazioni 173
• Fermentazione omoacetica dei clostridi
• Fermentazione degli amminoacidi
5.2 Metabolismo respiratorio 178
5.2.1 Respirazione aerobia dei batteri chemioeterotrofi 178
• Ciclo degli acidi tricarbossilici
• Vie anaplerotiche
5.2.2 Respirazione anaerobia dei batteri chemioeterotrofi 180
• Nitrato come accettore finale di elettroni
• Solfato come accettore finale di elettroni (riduzione dissimilativa del solfato) • Fe3+ e altri possibili accettori di elettroni organici e inorganici • Metanogenesi e acetogenesi
5.3 Diversità delle fonti organiche di energia 185
5.3.1 Catabolismo dei carboidrati 189
5.3.2 Catabolismo dei lipidi 190
5.3.3 Catabolismo di proteine e amminoacidi 190
5.3.4 Energia da composti organici a un atomo di carbonio: metilotrofia 191
5.3.5 Catabolismo degli idrocarburi e dei composti xenobiotici 196
ENERGIA DA REAZIONI DI OSSIDAZIONE
DI COMPOSTI INORGANICI
5.4 Microrganismi chemiolitotrofi 199
5.4.1 Ossidazione dell’idrogeno molecolare: batteri H2-ossidanti 199
5.4.2 Ossidazione dei composti ridotti dello zolfo: batteri zolfo-ossidanti o solfobatteri 200
5.4.3 Ossidazione del ferro (Fe2+): batteri ferro-ossidanti 202
5.4.4 Ossidazione dell’azoto: batteri nitrificanti 203
5.4.5 Batteri “comammox”: Nitrospira inopinata, un chemiolitoautotrofo che ossida l’ammonio a nitrato 204
5.4.6 Ossidazione anaerobia dell’azoto: batteri “anammox” 205
� Scheda 5.1 I batteri lattici 164
� Scheda 5.2 I bifidobatteri 165
� Scheda 5.3 Zymomonas e la fermentazione alcolica 169
� Scheda 5.4 I batteri enterici 170
� Scheda 5.5 I clostridi 176
� Scheda 5.6 La fermentazione acetica: un’ossidazione incompleta 176
� Scheda 5.7 Metanogenesi e acetogenesi 186
� Scheda 5.8 I batteri metofili 193
� Scheda 5.9 Pseudomonadaceae e Pseudomonas 197
6.4 Pigmenti fotosintetici e membrane fotosintetiche 210
6.5 Fototrofia basata su clorofilla e batterioclorofilla: pompe protoniche secondarie 212
6.6 Fotosintesi anossigenica 214
6.6.1 Ciclo fotosintetico secondario, fotofosforilazione e sintesi di NADH 214
6.7 Cianobatteri e fotosintesi ossigenica 216
6.7.1 Flusso di elettroni nella fotosintesi ossigenica 216
6.7.2 Sintesi di ATP (flusso ciclico e non ciclico) 217
6.8 Aspetti tassonomici e fisiologici dei batteri fotosintetici 218
6.8.1 Phylum Cyanobacteriota (cianobatteri) 218 • Strutture cellulari e differenziamento • Fisiologia e metabolismo • Ecologia dei cianobatteri
6.8.2 Phylum Pseudomonadota 223
6.8.3 Clado dei batteri aerobi che contengono batterioclorofille 225
6.8.4 Phylum Chlorobiota (batteri verdi sulfurei) 225
6.8.5 Phylum Chloroflexota (batteri verdi non sulfurei) 226
6.8.6 Phylum Bacillota 226
6.8.7 Phylum Acidobacteriota 226
6.8.8 Phylum Gemmatimonadota 227
6.9 Fototrofia basata sulla batteriorodopsina: pompe protoniche primarie 227
6.9.1 Fototrofia negli archei 227
6.9.2 Rodopsine nei procarioti 227
6.10 Microrganismi con doppia fototrofia: coesistenza di RC-BR e RC-Bchl 228
Scheda Web 6.1 Genetica della fotosintesi anossigenica e risposta all’ossigeno e alla luce Assimilazione,
di Anna Maria Sanangelantoni e Davide Zannoni
7.1 Come i procarioti si procurano il carbonio: eterotrofia
7.2 Come i procarioti si procurano il carbonio: autotrofia
7.2.1
7.2.2
7.4 Assimilazione di zolfo, fosforo e ferro
7.4.1 Zolfo
7.5 Strategie delle vie biosintetiche 243
7.5.1 Biosintesi degli amminoacidi e dei nucleotidi243
7.5.2 Sintesi dei lipidi 245
7.5.3 Biosintesi delle sostanze di riserva del carbonio 246
7.6 Cicli biogeochimici: carbonio, azoto, zolfo, fosforo e ferro 246
7.6.1 Il ciclo del carbonio
7.6.2 Il ciclo dell’azoto
• 1. Fissazione dell’azoto • 2. Riduzione dissimilativa del nitrato ad ammonio (DNRA)
• 3. Mineralizzazione della materia organica con liberazione di ammoniaca
• 4. Nitrificazione • 5. Ossidazione completa dell’ammoniaca a nitrato (comammox)
• 6. Denitrificazione aerobia e/o anaerobia
• 7. Riduzione dei nitriti con ossidazione anaerobia dell’ammonio (anammox)
7.6.3 Il ciclo dello zolfo 252
7.6.4 Il ciclo del fosforo 254
7.6.5 Il ciclo del ferro 254
� Scheda 7.1 L’azotofissazione 239
� Scheda 7.2 Sulfamidici e analoghi dell’acido folico [di Margherita Sosio] 244

8.1.1 Struttura fisica del nucleoide 259 • Proprietà topologiche del DNA
8.1.2 Architettura del cromosoma batterico 262 • Numero, struttura e dimensioni dei cromosomi batterici • Organizzazione genetica del cromosoma • Caratteristiche dell’organizzazione del cromosoma
8.2 Elementi genetici accessori 270
8.2.1 Plasmidi 270
• Replicone plasmidico: gruppi di incompatibilità, esclusione e spettro d’ospite
8.2.2 Elementi genetici trasponibili: sequenze IS e trasposoni 276
• Elementi IS • Trasposoni compositi e trasposoni semplici • Altri elementi trasponibili
8.2.3 Elementi virali 278
8.2.4 Integroni 278
8.2.5 Retroelementi procarioti 279
8.2.6 Ruolo degli elementi genetici accessori nell’evoluzione batterica 279
8.3 Mappe genetiche dei procarioti 280
8.4 Genoma degli Archaea 282
� Scheda 8.1 Lo stato topologico del DNA 261
� Scheda 8.2 Il genoma di Borrelia burgdorferi 264
� Scheda 8.3 Corrispondenza tra complessità metabolica e dimensioni del genoma 266
� Scheda 8.4 La scoperta dei plasmidi che conferiscono resistenza agli antibiotici 271
� Scheda 8.5 Architetture diverse dei genomi dei procarioti 273
� Scheda 8.6 Esempi di plasmidi modello 274
Scheda Web 8.1 La membrana nucleare del batterio Gemmata obscuriglobus e l’origine del nucleo degli eucarioti
Scheda Web 8.2 Proteine strutturali NAP e SMC e condensazione del DNA
Scheda Web 8.3 Metodi per identificare i plasmidi
Scheda Web 8.4 Un esperimento di trasposizione
Trasmissione
di Luciano Paolozzi
REPLICAZIONE DEL DNA
9.1 Proteine della replicazione 286
9.2 Inizio della replicazione
9.2.1 Origine di replicazione di Escherichia coli
• Proteina DnaA
9.2.2 Inizio e meccanismi di controllo della replicazione
9.3 Innesco della sintesi e allungamento del DNA
• Replisoma • Attività congiunta della DNA elicasi e della primasi • Progressione del replisoma lungo il DNA • Fedeltà della replicazione durante l'allungamento
9.4 Terminazione e risoluzione (separazione) dei nuovi cromosomi
9.5 Replicazione negli Archaea
RICOMBINAZIONE
9.6 Ricombinazione omologa
9.7 Ricombinazione negli Archaea
9.8 Ricombinazione non omologa
9.8.1 Ricombinazione sito-specifica
298 • Enzimi e bersagli della ricombinazione sito-specifica • Ricombinazione additiva del DNA dei batteriofagi temperati e altri elementi genetici • Inversione programmata di sequenze di DNA e regolazione dell’espressione genica a livello di popolazione
9.8.2 Trasposizione
• Caratteristiche generali della trasposizione
• Meccanismo molecolare della trasposizione nei procarioti
INTEGRITÀ DELL’INFORMAZIONE
GENETICA E GENERAZIONE DI MUTAZIONI
303
9.9 Mutanti batterici 305
9.10 Natura delle mutazioni ed eventi che ne provocano l’insorgenza 307
9.10.1 Errori di replicazione e mutazioni dirette 308
9.10.2 Mutazioni che derivano da danni al DNA 309
9.11 Meccanismi di riparazione che mantengono l’integrità dell’informazione genetica 310
9.11.1 Rettifica di misappaiamenti 310
9.11.2 Riparazione dei danni del DNA 311
• Coordinamento dei sistemi di riparazione dei danni al DNA: il sistema SOS
9.12 Frequenza delle mutazioni spontanee 311
9.12.1 Controllo della fedeltà nella trasmissione dell’informazione genetica 313
9.12.2 Ipermutazione 314
9.13 Mutazioni, selezione e adattamento batterico 314
9.13.1 Test di fluttuazione di Luria e Delbrück (1943) 315
9.14 Mutazioni post-adattative 318
� Scheda 9.1 Le DNA polimerasi 287
� Scheda 9.2 La regolazione dell’inizio della replicazione nei batteri 290
� Scheda 9.3 Antibiotici inibitori della replicazione del DNA [di Stefania Stefani e Margherita Sosio] 294
�
Scheda 9.4 Inversione geneticamente programmata di segmenti genomici come meccanismo di regolazione genica 301
� Scheda 9.5 Strategie di sopravvivenza al danno del DNA in Deinococcus radiodurans 312
� Scheda 9.6 I batteri e la sconfitta della roccaforte del lamarckismo 315
Scheda Web 9.1 Pol I, l’enzima Eureka e le altre DNA polimerasi
Scheda Web 9.2 Altre proteine necessarie per la replicazione
Scheda Web 9.3 Il primosoma nei batteri
Scheda Web 9.4 L’inizio della replicazione nei batteri con più cromosomi
Scheda Web 9.5 L’assemblaggio ciclico della primasi e DNA polimerasi III sul lagging strand e sintesi dei frammenti di Okazaki
Scheda Web 9.6 La replicazione dei cromosomi lineari
Scheda Web 9.7 La replicazione degli elementi extracromosomali e il suo controllo
Scheda Web 9.8 Modelli e meccanica della ricombinazione omologa
Scheda Web 9.9 L’evoluzione dei modelli di ricombinazione: dalla “scelta della copia” alla “rottura a doppia elica”
Scheda Web 9.10 L’integrazione di λ
Scheda Web 9.11 Meccanismi di trasposizione nei procarioti
Scheda Web 9.12 Agenti mutageni
Scheda Web 9.13 Meccanismi di riparazione dei danni al DNA
Scheda Web 9.14 Selezione indiretta di mutazioni adattative
di Luciano Paolozzi
10.1 Meccanismi del trasferimento genico orizzontale (TGO) 321
10.2 Coniugazione 322
10.2.1 Plasmide coniugativo F 326 • Struttura fisica e organizzazione genetica e funzionale
10.2.2 Trasferimento di marcatori cromosomali mediante coniugazione e F-duzione 328
10.2.3 Plasmidi coniugativi in altri batteri Gram negativi e nei Gram positivi 330 • Coniugazione interspecie
10.3 Trasformazione batterica 331
10.3.1 Natura del DNA trasformante 331
10.3.2 Competenza e apparati di trasformazione 332
10.3.3 Destino del DNA trasformante 335
10.3.4 Meccanismi e condizioni per la traslocazione del DNA trasformante 335
10.3.5 Significato biologico della competenza
10.3.6 Competenza artificiale
10.4.1 Trasduzione generalizzata
10.5 Trasferimento genico orizzontale in natura 339
10.5.1 Coniugazione 339
10.5.2 Trasformazione 340
10.5.3 Trasduzione 340
10.5.4 Barriere contro il trasferimento genico orizzontale 341
10.5.5 Integrazione di DNA estraneo nel genoma batterico 341
10.5.6 Ruolo del trasferimento genico orizzontale nell’evoluzione 342
� Scheda 10.1 La scoperta della coniugazione e della ricombinazione nei batteri 323
� Scheda 10.2 La scoperta della trasformazione: un esempio del carattere imprevedibile del percorso scientifico 332 � Scheda 10.3 La competenza: uno stato fisiologico regolato e transiente nelle cellule batteriche 335
Scheda Web 10.1 I meccanismi della coniugazione
Scheda Web 10.2 La traslocazione del DNA nei processi coniugativi Trascrizione e traduzione
di Luciano Paolozzi e Marco Bazzicalupo
11.1 Trascrizione nei batteri
11.1.1 RNA polimerasi batterica 347 • Nucleo catalitico dell’RNA polimerasi
11.1.2 Fasi della trascrizione 348 • Riconoscimento del promotore e inizio della trascrizione • Fase di polimerizzazione (allungamento del trascritto) • Fattori σ e varie forme di oloenzimi • Terminazione della trascrizione
11.1.3 Segnali sul DNA che regolano l’inizio della trascrizione 353 • Sequenze dei promotori e regioni di regolazione • Elementi di controllo positivo e negativo dell’inizio della trascrizione • Espressione dei geni e fattori che regolano la trascrizione
11.2 Trascrizione negli Archaea
11.2.1 RNA polimerasi e apparato di trascrizione 355
11.2.2 Regolatori della trascrizione 356
11.3 Traduzione nei batteri
11.3.1 Inizio della traduzione
11.3.2 Fase di elongazione 365
11.3.3 Terminazione della traduzione 366
11.4 Traduzione in Archaea ed eucarioti 366
� Scheda 11.1 Associazione dei fattori σ alternativi con l’RNA polimerasi nelle risposte adattive [di Stefania Stefani e Margherita Sosio] 351
� Scheda 11.2 Antibiotici inibitori della trascrizione [di Stefania Stefani e Margherita Sosio] 356
� Scheda 11.3 Antibiotici inibitori della sintesi proteica 360
Scheda Web 11.1 Meccanismi di capping e di poliadenilazione nei Bacteria
di Luciano Paolozzi
12.1 Aspetti generali della regolazione genica 368
12.1.1 Sistemi di regolazione delle funzioni cellulari e livelli di regolazione 368
12.1.2 Elementi del controllo dell’espressione genica 369
12.2 Primi modelli di regolazione: gli operoni catabolici degli zuccheri 370
12.2.1 Operone lac per l’utilizzazione del lattosio. Modello classico di regolazione negativa e controllo positivo di cAMP·CRP 371
• Repressione da catabolita e diauxia
12.2.2 Regulone maltosio: esempio di regolazione positiva 374
• Il prodotto del gene regolatore malT è un attivatore trascrizionale
12.2.3 Operone arabinosio: regolazione positiva e negativa con una sola proteina (e l’aiuto di CRP) 375
12.2.4 Utilizzazione del galattosio: un regulone complesso 376
• Significato della presenza dei due promotori nell’operone gal
12.3 Trasduzione del segnale: sistemi di regolazione a due componenti 378
12.4 Modelli di regolazione della biosintesi degli amminoacidi 380
12.4.1 Regolazione feedback dell’attività enzimatica 380
12.4.2 Regolazione trascrizionale dell’operone trp 382
• Repressione • Attenuazione in Escherichia coli • Attenuazione in Bacillus subtilis
12.4.3 Risposta stringente: un meccanismo di regolazione della fisiologia batterica in risposta alla carenza di amminoacidi 386
• Meccanismo e conseguenze dell’induzione della sintesi di (p)ppGpp
12.5 Modelli di regolazione globale 389
12.5.1 Risposta a stress da calore
12.5.2 Regolazione del regulone σH in Escherichia coli
12.5.3 Sistema SOS di Escherichia coli
389
390
390
12.6 Altri sistemi di regolazione genica 391
12.6.1 Regolazione genica mediante “interruttori a RNA” (riboswitch) 391
12.6.2 RNA con funzione regolatrice 393
12.7 Controllo spazio-temporale dell'espressione genica: la sporulazione, un modello di differenziamento cellulare
12.7.1 Geni della sporulazione
12.7.2 Fosforelè
396
396
396
12.7.3 Cascata dei fattori σ e regolazione spazio-temporale 397
� Scheda 12.1 Il trasporto del lattosio nella cellula: il segnale intracellulare della presenza del lattosio
372
� Scheda 12.2 La regolazione post-trascrizionale nei procarioti 394
Scheda Web 12.1 Storia di una teoria scientifica: l’operone lac, il sistema modello di regolazione genica
Scheda Web 12.2 La resistenza al mercurio e l’attivazione del promotore merT
Scheda Web 12.3 Regolazione trascrizionale dei meccanismi di competenza
Scheda Web 12.4 La riattivazione W delle particelle fagiche e la scoperta del sistema SOS
cellulare e differenziamento
399 di Orietta Massidda e Luciano Paolozzi
13.1 Divisione cellulare nei procarioti 399
13.1.1 Divisione cellulare nel batterio modello Escherichia coli
400
13.1.2 Assemblaggio dell’apparato di divisione cellulare (divisoma) 402
• Coordinamento della divisione cellulare con l’accrescimento laterale
• Coordinamento della divisione cellulare con la replicazione del DNA
• Coordinamento tra tempo di generazione e tempo di replicazione del DNA durante il ciclo cellulare
13.1.3 Controllo spaziale e temporale della formazione del setto di divisione cellulare in Escherichia coli 407
13.1.4 Segregazione del DNA durante il ciclo cellulare 408
• Segregazione del nucleoide
• Segregazione dei plasmidi
• Altri meccanismi di controllo della stabilità plasmidica
13.1.5 Divisione cellulare in Bacillus subtilis 411
13.1.6 Divisione cellulare nei batteri modello di forma sferica o sferico-ovoidale 413
13.2 Caulobacter crescentus: un modello di divisione cellulare asimmetrica 413
13.2.1 Ciclo cellulare di Caulobacter crescentus 414
• Rete di regolazione a cascata e controllo delle sintesi macromolecolari
• Controllo spaziale della distribuzione cellulare di CtrA • Controllo temporale di CtrA • Controllo della replicazione del DNA e della segregazione del nucleoide
13.2.2 Modalità alternative di divisione cellulare 419
• Divisione per scissioni multiple
• Gemmazione nei batteri prostecati
13.3 Differenziamento cellulare nei procarioti 420
� Scheda 13.1 L’anello Z dei plastidi e l’origine degli eucarioti 401
Scheda Web 13.1 La complessa regolazione delle proteine di divisione
Scheda Web 13.2 L’occlusione del nucleoide e le proteine anti-ghigliottina
Scheda Web 13.3 Le proteine del citoscheletro batterico nei processi di divisione e differenziamento

di Giorgio Gribaudo
14.1 Struttura e organizzazione dei virioni
14.1.1 Diversità dei genomi virali
14.1.2 Capside
14.1.3 Involucro pericapsidico (envelope)
14.2 Classificazione
14.2.1
Luciano Paolozzi e Gianni Dehò
15.1 Struttura, organizzazione e studio
15.1.1 Involucro proteico di alcuni batteriofagi modello
• Virione del batteriofago T4 • Virione del batteriofago λ • Capside dei fagi filamentosi
15.1.2 Genomi dei batteriofagi
15.1.3 Diversità dei batteriofagi e modelli di studio
15.1.4 Titolazione dei batteriofagi mediante il saggio di placca 440 15.2 Riproduzione dei
• L’esperimento “singolo ciclo di crescita” • Adsorbimento • Penetrazione dell’acido nucleico nel batterio ospite • Trascrizione dei genomi fagici • Replicazione dei genomi fagici • Morfogenesi virale: assemblaggio dei componenti e impacchettamento del DNA • Rilascio e disseminazione
15.2.2 Ciclo lisogeno dei fagi temperati 448 15.3 Analisi genetica dei fagi
15.4 Alcuni esempi di batteriofagi utilizzati come modello di studio
15.4.1 I fagi della serie T 449 • Batteriofago T4, modello dei fagi litici • Trascrizione di T4 • Replicazione del batteriofago T4 • Inizio della replicazione
15.4.2 I batteriofagi a RNA 451 • Batteriofagi a ssRNA • Batteriofagi a dsRNA
15.4.3 I fagi a ssDNA filamentosi e isometrici
15.4.4 Il batteriofago λ: l’elemento genetico più finemente caratterizzato 454 • Genoma di λ • Trascrizione a cascata del batteriofago λ • Replicazione di λ e ciclo litico • Maturazione del batteriofago λ • Ciclo lisogeno del batteriofago λ
15.4.5 Il profago-plasmide del batteriofago trasducente P1 457
15.4.6 Altri sistemi modello 458
15.5 Difese batteriche contro l’infezione dei batteriofagi 459
15.6 Batteriofagi contro le infezioni batteriche: la terapia fagica 464
15.7 Virus degli Archaea 465
� Scheda 15.1 Modificazione e restrizione del DNA: il riconoscimento del “self” dal “non self” 458
� Scheda 15.2 CRISPR-Cas: un sistema adattivo di resistenza ai fagi guidato da piccoli RNA 460
Scheda Web 15.1 Alla ricerca delle leggi “complementari” della fisica: la nascita del gruppo del fago e della biologia molecolare
Scheda Web 15.2 Applicazioni dell’uso dei batteriofagi
Scheda Web 15.3 Calcolo delle cellule infettate da un virus e molteplicità di infezione
Scheda Web 15.4 L’adsorbimento del fago alla cellula ospite
Scheda Web 15.5 Ciclo litico e ciclo lisogeno del batteriofago λ: la scelta tra due destini alternativi
Scheda Web 15.6 Lisare o non lisare? Un problema aperto tra caso, genetica ed epigenetica
Scheda Web 15.7 Il profago-plasmide lineare del batteriofago N15
Scheda Web 15.8 Il batteriofago-trasposone Mu
Scheda Web 15.9 Sistemi di antirestrizione, una lotta senza fine
I virus degli eucarioti 469
di Giorgio Gribaudo
16.1 I virus degli animali 469
16.1.1 Modalità di studio dei virus animali 469
• Sistemi ospite: animali, uova, colture cellulari • Effetto citopatico • Analisi quantitativa: metodo delle placche
16.1.2 Modelli di infezione 472
• Infezione litica • Infezione persistente di tipo cronico • Infezione persistente di tipo latente • Infezione cronica di tipo trasformante (virus oncogeni);
16.1.3 Risposta dell’ospite all’infezione 475
• Immunopatologia • Evasione della risposta immunitaria
16.1.4 Modelli di virus animali 477
• Classe I – Virus a dsDNA: herpesvirus, adenovirus, poxvirus
• Classe II – Virus a ssDNA: parvovirus
• Classe III – Virus a dsRNA: reovirus
• Classe IV – Virus a (+)ssRNA: picornavirus (polio), flavivirus, coronavirus
• Classe V – Virus a (‒)ssRNA: rhabdovirus, paramyxovirus, orthomyxovirus, virus Ebola
• Classe VI – Virus a (+)ssRNA con retrotrascrizione: retrovirus
• Classe VII – Virus parzialmente a dsDNA con retrotrascrizione: hepadnavirus
16.2 I virus dei vegetali
16.2.1 Virus del mosaico del tabacco (TMV)
16.2.2 Virus di Chlorella
16.3 Agenti subvirali e prioni
16.4.1 Inibizione dell’adsorbimento e della penetrazione del virus
16.4.2 Inibizione della replicazione del genoma virale
506
507
16.4.3 Inibizione dell’assemblaggio virale e della maturazione 507
� Scheda 16.1 Grandi virus a DNA nucleocitoplasmatici (NCLDV): un nuovo enigma o una tappa verso nuove conoscenze? 479
� Scheda 16.2 Peste suina africana: una malattia virale riemergente 484
� Scheda 16.3 La pandemia di COVID-19 e l’evoluzione di SARS-CoV-2 in tempo reale 489
� Scheda 16.4 Il virus Ebola e le caratteristiche di recenti epidemie di un virus emorragico 494

Analisi globale delle cellule microbiche: le discipline omiche
di Marco Rinaldo Oggioni, Marco Bazzicalupo e Alessio Mengoni
17.1.2 Annotazione 512
17.1.3 Genoma condiviso, genoma accessorio e pangenoma 514
17.1.4 Analisi genomica comparativa 514
17.2 Metagenomica 515
17.3 Genomica funzionale 516
17.3.1 Trascrittomica 516
17.3.2 Proteomica 518
17.4 Metabolomica e screening fenotipico 518
17.5 Biologia dei sistemi 519
� Scheda 17.1 Trascrittomica tramite sequenziamento dell’RNA 517
Scheda Web 17.1 Analisi proteomica mediante spettrometria di massa
di Giovanna Felis, Gabriele Andrea Lugli, Anna Maria Sanangelantoni e Marco Bazzicalupo
� Scheda 18.3 Storia della classificazione e della nomenclatura dei batteri 524
� Scheda 18.4 La tassonomia numerica e la similarità dei microrganismi 528
� Scheda 18.5 Costruire un albero filogenetico 538
Scheda Web 18.1 Funghi
Scheda Web 18.2 Saccharomyces cerevisiae: un microrganismo eucariote modello [di Giovanna Lucchini]
Scheda Web 18.3 Alghe
Scheda Web 18.4 Protozoi

520
18.1 Concetti base di sistematica microbica 521
18.1.1 Ceppi, specie e coltivabilità 521
18.1.2 Classificazione 522
18.1.3 Identificazione 522
18.1.4 Nomenclatura 524
18.1.5 Importanza delle tecniche di indagine nella classificazione e caratterizzazione dei microrganismi 526
18.2 Filogenesi molecolare 530
18.2.1 Evoluzione e filogenesi 530
18.2.2 Sequenze usate nella filogenesi molecolare di procarioti ed eucarioti 530
18.2.3 Uso delle sequenze genomiche per la classificazione e l’identificazione microbica 537
18.3 Identificazione e classificazione della biodiversità non coltivabile 541
18.3.1 Microrganismi non coltivabili e microbiomi 542
18.3.2 Approcci alla nomenclatura delle sequenze 545
18.4 Gruppi tassonomici 546
18.4.1 Bacteria 547
18.4.2 Archaea 553
18.4.3 Microrganismi eucarioti 555 • Funghi e lieviti • Alghe • Protozoi
� Scheda 18.1 Eventi rilevanti nella storia della Terra 521
� Scheda 18.2 Risorse disponibili per la sistematica dei microrganismi procarioti 523
Microbiologia ambientale ed ecologia microbica 560 di Andrea Franzetti
19.1 Dalla popolazione all’ecosistema microbico 561
19.2 Processi ecologici 564
19.2.1 Comunità microbiche versus comunità di macrorganismi 564
19.2.2 Sintesi concettuale dell’ecologia delle comunità microbiche 565
• Selezione • Dispersione
• Neve marina • Ficosfera 18 19
• Diversificazione (speciazione)
• Deriva ecologica
19.3 Habitat microbici terrestri 566
19.3.1 Microbioma del suolo 566
19.3.2 Effetto del microbioma sulla struttura e proprietà del suolo 567
19.3.3 Legame tra struttura e funzioni nel microbioma del suolo 568
19.4 Habitat microbici marini 568
19.4.1 Zona pelagica 569
• Composizione delle comunità microbiche nella zona pelagica
19.4.2 Oceano profondo 571
• Diversità filogenetica e funzionale
19.4. 3 Sedimenti marini 572
19.4.4 Microhabitat marini: la neve marina e la ficosfera 573
19.5 Habitat estremi 573
19.5.1 Sorgenti geotermali terrestri 576
19.5.2 Sorgenti idrotermali marine profonde 576
19.5.3 Criosfera 577
19.5.4 Ambienti ipersalini 578
19.5.5 Drenaggio acido delle miniere 578
19.5.6 Altri ambienti estremi 578
19.6 Habitat antropizzati e costruiti 579
19.6.1 Habitat microbici urbani 579
• Sistemi di trasporto urbano
• Microbiomi dell’aria
19.6.2 Microbiologia applicata all’ambiente e alla transizione energetica 581
• Biorisanamento • Utilizzo dei
microrganismi per il recupero di materiali e produzione di energia dagli scarti
� Scheda 19.1 Un approccio operativo per descrivere le comunità microbiche 562
� Scheda 19.2 I batteri ubiquitari Synechococcus, Prochlorococcus e SAR11 571
� Scheda 19.3 Limiti chimico-fisici della vita microbica sulla Terra e proiezione su altri pianeti 575
� Scheda 19.4 La biogeoalbedo 577
tra batteri: strategie di cooperazione e competizione 584
di Paolo Landini
20.1 Comunicazione intercellulare: il “quorum sensing” 586
20.1.1 Quorum sensing nei batteri Gram negativi 587
20.1.2 Ruolo del quorum sensing nell’interazione batteri-organismi eucarioti e come bersaglio di nuovi antimicrobici 592
20.1.3 Quorum sensing in batteri Gram positivi 593
20.1.4 Quorum sensing e sua relazione con la produzione di agenti antimicrobici 595
20.1.5 Altre molecole con funzione di autoinduttori 596
20.2 Associazioni microbiche: i biofilm 596
20.2.1 Definizione generale 597
20.2.2 Formazione del biofilm e sua architettura 597
20.2.3 Macromolecole e strutture cellulari batteriche coinvolte nella formazione del biofilm 599
20.2.4 Meccanismi di regolazione genica legati al biofilm 600 • Fattori ambientali e sistemi di regolazione a due componenti • Ruolo del quorum sensing nel biofilm • Molecole segnale derivate da nucleotidi
20.2.5 Biofilm microbico nella prospettiva ecologica e nel contesto delle malattie infettive 604
20.3 Antibiotici nell’interazione tra microrganismi 606
� Scheda 20.1 Vibrio fischeri: il primo modello di quorum sensing regolato da omoserin-lattoni 587
� Scheda 20.2 Il quorum sensing come dimostrazione del valore intrinseco della ricerca di base 589
� Scheda 20.3 DI-GMP ciclico e suo ruolo nella produzione della cellulosa e nella formazione del biofilm 603
dei microrganismi con gli organismi vegetali 609 di Pietro Alifano
21.1 Rizosfera e fillosfera 609
21.1.1 Modificazione della rizosfera da parte di batteri e funghi 610
21.1.2 Micorrize 611 • Ectomicorrize • Endomicorrize
21.1.3 Batteri azotofissatori endosimbionti 613
21.1.4 Rizobi e leguminose 614
21.2 Riconoscimento dei batteri patogeni e meccanismi di difesa delle piante 617
21.2.1 Immunità innata primaria: il sistema MAMP-PRR nelle piante 617
21.2.2 Immunità innata secondaria: geni di resistenza (R) delle piante e di avirulenza (avr) dei batteri 618
21.2.3 Resistenza sistemica acquisita (SAR) e resistenza sistemica indotta (ISR) 620
21.3 Agrobacterium e induzione di tumori nelle piante 621
21.3.1 Genere Agrobacterium e patologie tumorali vegetali indotte dalle specie virulente 621
21.3.2. Processo di trasformazione tumorale: il plasmide Ti, il T-DNA e le interazioni batterio-pianta 622
21.4 Utilizzo dei microrganismi della rizosfera e dei loro prodotti nelle nuove tecnologie agrarie 624 � Scheda 21.1 Altri tipi di micorrize 612
Il microbiota
626 di Marco Ventura e Francesca Turroni
22.1 Popolazioni microbiche sulla Terra 626
22.2 Microbiota e microbioma dell’essere umano 627
22.3 Il concetto di olobionte e olobioma 629
22.4 Il microbiota umano nelle diverse fasi della vita 629
22.5 Eubiosi e disbiosi microbiche e loro impatto sulla salute dell’essere umano 631
22.6 Fattori coinvolti nel modulare la composizione del microbiota 632
22.7 Funzioni svolte dal microbiota umano 632
22.8 Correlazioni microbiota e malattie: i nuovi marcatori microbici 634
22.9 La “batterioterapia” come nuovo approccio terapeutico 636
22.10 Il microbiota nei diversi distretti del corpo umano 636
22.10.1 Microbiota della cute 636
22.10.2 Microbiota orale 638
22.10.3 Microbiota polmonare 638
22.10.4 Microbiota intestinale 638
22.10.5 Microbiota vaginale 640
22.11 Ruolo del microbiota intestinale negli animali da allevamento e da compagnia 641
� Scheda 22.1 Gli oligosaccaridi del latte materno 631
� Scheda 22.2 Asse intestino-cervello 634
� Scheda 22.3 Microbiota e obesità 635
� Scheda 22.4 Fecal Microbiota Transplantation (FMT) 637
� Scheda 22.5 Farmacomicrobiomica 639
Interazioni con gli organismi animali: la patogenesi 642
di Maria Lina Bernardini e Marco Oggioni
23.1 Patogenicità e virulenza batterica: due concetti da definire 642
23.2 Batteri patogeni, postulati di Koch e misura della virulenza 643
23.3 Importanza del DNA acquisito mediante trasferimento genico orizzontale 645
23.4 Fattori di virulenza dei batteri patogeni 652
23.5 Fattori di adesione come mediatori della virulenza batterica 654
23.6 Invasività, effettori batterici e invasine 656
23.7 Stili di vita dei batteri invasivi 659
23.8 Tossine: “frecce” molecolari dei batteri patogeni 660
23.8.1 Tossine che agiscono dall’esterno della cellula 661
• Superantigeni: le tossine degli streptococchi e degli stafilococchi • Tossine che formano pori sulla superficie cellulare
23.8.2 Tossine solubili con bersagli intracellulari 662
• Struttura A/B delle tossine • Tossine ad attività ADP-ribosilante
23.8.3 Neurotossine 664
23.9 Regolazione dei geni di virulenza, un aspetto essenziale della patogenicità microbica: il modello di Vibrio cholerae 667
23.9.1 Ciclo infettivo di Vibrio cholerae 667
23.9.2 Regolazione dei geni di virulenza di Vibrio cholerae 668
� Scheda 23.1 Helicobacter pylori e l’epitelio gastrico 644
� Scheda 23.2 Modelli controllati di infezione umana 646
� Scheda 23.3 Come Salmonella divenne un batterio patogeno 648
� Scheda 23.4 Le forme patogene di Escherichia coli 650
Scheda Web 23.1 Eventi regolativi nella virulenza di Salmonella enterica

DISPONIBILE IN DIGITALE Immunità innata 672 di Maria Lina Bernardini
24.1 Difese fisiche contro i patogeni 673
24.2 Immunità innata: un sistema di difesa ancestrale 677
24.2.1 PAMP, Pathogen-Associated Molecular Patterns – Strutture batteriche 678
24.2.2 PRR, Pattern Recognition Receptors 680
24.2.3 PRR di membrana: i recettori Toll-like 681
24.2.4 PRR citosolici: le proteine NLR 683
24.3 Cellule del sistema immunitario: la popolazione eterogenea dei leucociti 687 23
23.6.1 Meccanismi molecolari dell’invasività batterica: trigger e zipper 656
24.4 Neutrofili, una popolazione cellulare sulla prima linea di difesa 688
24.5 Macrofagi (fagociti mononucleati) 691
24.6 Cellule natural killer 692
24.7 Sistema del complemento 692
24.8 Citochine 694
24.9
24.10 Processo di “evasione immune” dei batteri patogeni 696
24.10.1 Difese “strutturali” dei microrganismi 697
24.10.2 Evasione dalla difesa delle barriere della cellula ospite 698
24.10.3 “Camuffamento”, strategia per diminuire il riconoscimento da parte del sistema immunitario innato 699
24.10.4 Cambiamento delle strutture di superficie per imbrogliare il sistema immunitario dell’ospite 699
24.10.5 Fagosoma: strategia di difesa 700
� Scheda 24.1 Le cellule M dell’intestino: il “tallone di Achille” dell’epitelio intestinale 675
� Scheda 24.2 Toll vs Imd: le armi molecolari di Drosophila melanogaster 679
� Scheda 24.3 L’apoptosi o morte cellulare programmata: un suicidio cellulare 681
� Scheda 24.4 Le malattie infiammatorie dell’intestino e le proteine NLR 686
� Scheda 24.5 Shock settico e reazioni di Schwartzman 697
di Maria Lina Bernardini
703
25.1 Effettori dell’immunità adattativa: gli anticorpi 704
25.2 Tipologia degli anticorpi e loro ruolo 706
25.3 Selezione e sviluppo degli anticorpi 709
25.3.1 Organizzazione dei loci genici delle immunoglobuline 710
25.4 Meccanismi molecolari della diversità immunitaria 710
25.4.1 Ricombinazione somatica 711
25.4.2 Altri meccanismi della variabilità anticorpale 712
25.5 Linfociti T e riconoscimento degli antigeni 713
25.6 Organizzazione dei loci genici del TcR 714
25.7 Selezione dei linfociti T 714
25.8 Molecole del complesso maggiore di istocompatibilità (MHC) 716
25.8.1 MHC di classe I 716
25.8.2 MHC di classe I e presentazione degli antigeni 717
25.8.3 MHC di classe II 718
25.9 Cellule presentanti l’antigene (APC): cellule dendritiche 718
25.10 Linfociti T effettori: linfociti T helper e citotossici (CTL) 723
25.11 Linfociti T helper e polarizzazione della risposta 724
� Scheda 25.1 Il sistema immunitario delle mucose 709
� Scheda 25.2 Le cellule dendritiche e la mucosa intestinale 722
Crediti fotografici
Indice analitico A3
A questo indirizzo sono disponibili le risorse digitali di complemento al libro: universita.zanichelli.it/deho4e
Per accedere alla risorse protette è necessario registrarsi su my.zanichelli.it inserendo il codice di attivazione personale che si trova sull’etichetta adesiva nella prima pagina del libro.
Dal sito del libro è possibile:
• leggere le Schede web di approfondimento;
• esercitarsi con 16 Laboratori interattivi;
• trovare i link per i test interattivi di autovalutazione;
• accedere direttamente alla versione Ebook, contenenti tutti i capitoli dell’edizione a stampa e, in più, i Capitoli 24 e 25.
Le risorse digitali sono disponibili per chi acquista il libro nuovo. L’accesso all’Ebook e alle risorse digitali protette è personale, non condivisibile e non cedibile, né autonomamente né con la cessione del libro cartaceo.
I contenuti del libro sono organizzati in sette parti contraddistinte da un colore e da una fotografia.







Disponibile in digitale
Il testo è disponibile anche in versione Ebook, fruibile online e offline, mediante l’applicazione laZ Ebook, che permette di scegliere, in qualsiasi momento dello studio, se fruire il testo nella versione con impaginazione fissa, analoga al libro stampato, oppure in quella liquida con modalità immersiva. Quest’ultima consente, tra le altre cose, di ingrandire e
variare le font per una lettura più confortevole e di ascoltare il testo mediante la funzione del lettore vocale. Entrambe le versioni permettono di evidenziare il testo, prendere appunti, creare mappe concettuali e mettere segnalibri. Per accedere all’Ebook e agli altri contenuti digitali, seguire le istruzioni fornite nella prima pagina del libro.

Oltre 130 schede di approfondimento, in parte nel libro e in parte in digitale (Schede Web), arricchiscono lo studio.
� Le schede rosse sviluppano il tema degli antibiotici, un argomento ricorrente e trasversale a tutta l’opera
� Le schede verdi aiutano a capire e imparare la sistematica dei microrganismi
� Le schede viola permettono di approfondire argomenti specifici e tecniche
Rinnovato e ampliato per questa edizione, l’apparato iconografico costituisce un secondo livello di lettura del libro, che facilita la comprensione degli argomenti e dei processi più complessi.
Dal sito del libro è possibile accedere a test interattivi di autovalutazione che permettono di ripassare in modo attivo e di verificare la comprensione dei concetti studiati.

Completano il progetto 16 laboratori interattivi per simulare gli esperimenti più comuni che si svolgono nei laboratori di microbiologia, mettendo alla prova la propria capacità di risolvere questioni di laboratorio e permettendo di approfondire la conoscenza di strumenti e metodi.
Elenco dei laboratori disponibili
1. Preparazione di una soluzione fisiologica
2. Diluizioni seriali
3. Antibiogramma
4. Calcolo della Minima Concentrazione Inibente di un antibiotico
5. Curva di crescita
6. Curva di crescita con aggiunta di antibiotico
7. Osservazione di batteri al microscopio ottico a contrasto di fase
8. Colorazione delle spore
9. Colorazione di Gram
10. Elettroforesi su gel d’agarosio
11. Identificazione di una specie batterica mediante amplificazione per PCR del gene 16S
12. Preparazione di cellule competenti per elettroporazione
13. Elettroporazione batterica
14. Preparazione di cellule competenti per shock termico
15. Trasformazione per shock termico
16. Coniugazione batterica

Il libro Biologia dei microrganismi, pubblicato nella sua prima edizione nel gennaio 2012, venne alla luce grazie alla visione della professoressa Enrica Galli di realizzare un manuale che comprendesse tutti gli aspetti fondamentali della microbiologia, distinguendosi al tempo stesso dai pur ottimi testi già presenti sul mercato. Biologia dei microrganismi non nasce, infatti, come traduzione dall’inglese, ma è un testo redatto ab origine in italiano, con il contributo di docenti direttamente impegnati nell’insegnamento della microbiologia negli Atenei del nostro Paese, e quindi vicini alla sensibilità dei singoli corsi di laurea e alle esigenze dei nostri studenti e studentesse. La scrittura del libro si avvalse da subito dell’apporto collettivo e integrato di un significativo numero di autrici e autori, in base alle loro specifiche competenze scientifiche. Queste due prerogative, vale a dire attinenza alla realtà accademica italiana e coinvolgimento di ricercatrici e ricercatori esperti nei vari campi della microbiologia, sono rimaste una costante nei successivi aggiornamenti e revisioni del testo, e restano un asse portante di questa nuova edizione del libro, così come l’organizzazione del testo, le numerose schede di approfondimento di tematiche specifiche e l’ampia dotazione di materiale in digitale.
A più di dieci anni dalla prima edizione, a fronte dei significativi progressi in alcuni ambiti della microbiologia, quale lo studio delle comunità microbiche e della complessità delle loro interazioni con gli animali e l’ambiente, e alla luce delle emergenze microbiologiche emerse con la pandemia da SARS-CoV-2 del 2020-2021, si è ritenuto di mettere mano a una revisione più organica ed estesa del libro, includendo i professori Paolo Landini e Marco Ventura come curatori e allargando i contributi specifici fino a comprendere un totale di 26 autori. La nuova edizione di Biologia dei microrganismi è ora suddivisa in sei parti, più una settima disponibile solo in digitale, invece delle quattro dell’edizione precedente. La riorganizzazione in due nuove parti, Eredità infettiva: i virus e Genomica e sistematica , è finalizzata a dare un maggior rilievo alla virologia e agli approcci genomici nella microbiologia, aggiornando inoltre la sistematica dei microrganismi in base alle scoperte più recenti e alle nuove indicazioni internazionali. Inoltre, sono stati riorganizzati e maggiormente approfonditi i contenuti di microbiologia ambientale, e rivisti ed espansi temi cruciali come i cicli biogeochimici, i sistemi di comunicazione batterica, i meccanismi di virulenza e le strategie di adattamento.
Ringraziamo per la loro preziosa collaborazione tutti i nostri colleghi e colleghe che hanno messo a disposizione le loro specifiche competenze e ci auguriamo che la nuova edizione di Biologia dei microrganismi continui a incontrare l’interesse e l’apprezzamento di docenti, studenti e studentesse di Microbiologia.
Gianni Dehò
Enrica Galli
Paolo Landini
Marco Ventura
La terza edizione di questo libro nasce dall’esigenza di apportare ulteriori miglioramenti nella presentazione degli argomenti e i necessari aggiornamenti al testo originario. In particolare, Genetica microbica e Biologia molecolare, precedentemente affrontate in tre capitoli distinti, sono state riunite in un unico capitolo, il Capitolo 9, al fine di rendere più omogenea la trattazione e facilitare il compito degli studenti. Analogamente vengono trattati in unico capitolo, il Capitolo 14, i virus dei procarioti e i virus degli eucarioti. È stato inoltre condotto un accurato lavoro di aggiornamento sui testi e sulle figure ed è stata notevolmente ampliata e aggiornata la parte relativa agli antibiotici, anche con l’inserimento di nuove schede di approfondimento.
Un sentito ringraziamento va alla preziosa collaborazione dei numerosi colleghi che, con le loro specifiche competenze, hanno reso possibile la realizzazione di questa nuova edizione. Ci auguriamo che il manuale possa incontrare un rinnovato interesse da parte dei colleghi docenti di discipline microbiologiche e degli studenti.
Gianni Dehò Enrica Galli
Nata come scienza circa un secolo e mezzo fa, la Microbiologia (Biologia dei microrganismi) ha conosciuto negli ultimi sessant’anni una spettacolare evoluzione che ha contribuito in modo determinante a sviluppare l’attuale visione globale del mondo vivente e la comprensione, specialmente a livello molecolare, di processi biologici fondamentali. Utilizzando microrganismi come principale modello di studio, sono state poste le basi di importanti discipline biologiche, quali la biochimica, la biologia molecolare e la genetica molecolare; è stata decifrata la natura di DNA, RNA e proteine e sono state sviluppate le tecnologie che stanno alla base dell’ingegneria genetica e delle biotecnologie molecolari. Tappa finale di questo percorso che ha attraversato quasi tutto il XX secolo e che ha aperto nuovi orizzonti alla ricerca biologica è stato il sequenziamento del DNA e lo sviluppo degli approcci genomici allo studio dei sistemi biologici.
La Microbiologia ha quindi via via assunto un ruolo sempre più rilevante tra le discipline biologiche, sia come disciplina specialistica, sia per la visione globale e unificante che riesce a fornire del mondo vivente.
Questo libro tratta fondamentalmente di microrganismi procarioti (batteri e archei), pur facendo continui richiami al mondo eucariote, e in particolare ai microrganismi eucarioti, per quanto riguarda le differenze nella struttura e nelle funzioni a livello cellulare, l’evoluzione molecolare e i rapporti filogenetici fra i tre gruppi di microrganismi. Il testo è stato pensato in particolare per gli studenti dei corsi di Laurea triennali e magistrali in Scienze biologiche e Biotecnologie, aven-
do come riferimento gli insegnamenti di Microbiologia generale, Microbiologia cellulare e Microbiologia molecolare, ma la parte più generale del libro è utilizzabile anche da studenti di altri corsi di laurea scientifici.
Per venire incontro alle diverse esigenze didattiche, il testo è suddiviso in quattro parti di cui le prime due (Struttura e funzione della cellula procariote e Crescita microbica e metabolismo) rappresentano la parte di base della Microbiologia, mentre le altre due parti (Genetica batterica e biologia molecolare e Interazioni tra microrganismi e con altri organismi) affrontano aspetti propri della microbiologia molecolare e cellulare. Questo tipo di organizzazione vuole offrire al docente e allo studente la possibilità di conoscere il mondo dei microrganismi a livello strutturale e funzionale da un lato e cellulare-molecolare dall’altro. In questo modo il docente può scegliere gli argomenti più adatti agli insegnamenti della laurea triennale o magistrale, seguendo percorsi diversi a seconda del tipo e del livello di insegnamento.
Il testo si caratterizza inoltre anche per altri aspetti:
• il livello di aggiornamento e approfondimento dei vari aspetti della microbiologia al passo con i più recenti risultati delle ricerche microbiologiche, con un ampio materiale iconografico;
• la trattazione di argomenti più specifici in apposite schede di approfondimento. Per alleggerire il testo, alcune di queste schede sono disponibili in una sezione online sul sito dedicato al libro che in futuro potrà essere aggiornata e ampliata.
La stesura del testo si è avvalsa del prezioso contributo di numerosi docenti di discipline microbiologiche, che hanno messo a disposizione la propria competenza nella trattazione dei vari aspetti della Microbiologia. A loro va un sentito ringraziamento per la proficua collaborazione.
Ai colleghi docenti che sceglieranno di adottare questo testo e suggerirlo agli studenti come strumento di studio, chiediamo di farci avere commenti e suggerimenti che saranno utili in una futura revisione.
Gianni Dehò
Enrica Galli
Pietro Alifano , Dipartimento di Medicina sperimentale, Università del Salento
Loredana Baccigalupi , Dipartimento di Medicina molecolare e Biotecnologie mediche, Università degli Studi di Napoli “Federico II”
Marco Bazzicalupo, Dipartimento di Biologia, Università degli Studi di Firenze
Maria Lina Bernardini, Dipartimento di Biologia e Biotecnologie “Charles Darwin”, Sapienza Università di Roma
Gianni Dehò, Università degli Studi di Milano
Giovanna Felis , Dipartimento di Biotecnologie, Università di Verona
Andrea Franzetti, Dipartimento di Scienze dell’Ambiente e della Terra, Università degli Studi di Milano-Bicocca
Enrica Galli, Università degli Studi di Milano
Giorgio Gribaudo, Dipartimento di Scienze della Vita e Biologia dei Sistemi, Università di Torino
Paolo Landini, Dipartimento di Bioscienze, Università degli Studi di Milano
Giovanna Lucchini , Dipartimento di Biotecnologie e Bioscienze, Università degli Studi di Milano-Bicocca
Gabriele Andrea Lugli , Dipartimento di Scienze chimiche, della Vita e della Sostenibilità ambientale, Centro Interdipartimentale “Microbiome Research Hub”, Università degli Studi di Parma
Orietta Massidda , Centro Interdipartimentale di Scienze mediche - CISMED, Università di Trento
Alessio Mengoni , Dipartimento di Biologia, Università degli Studi di Firenze
Marco Rinaldo Oggioni , Dipartimento di Farmacia e Biotecnologie, Alma Mater Studiorum Università di Bologna
Luciano Paolozzi, Dipartimento di Scienze matematiche, fisiche e naturali, Università di Roma “Tor Vergata”
Alessandra Polissi, Dipartimento di Scienze farmacologiche e biomolecolari “Rodolfo Paoletti”, Università degli Studi di Milano
Anna Maria Puglia , Consorzio Italbiotec, Milano
Paola Quatrini , Dipartimento di Scienze della Terra e del Mare (DiSTeM), Università degli Studi di Palermo
Ezio Ricca , Dipartimento di Biologia, Università degli Studi di Napoli “Federico II”
Anna Maria Sanangelantoni, Dipartimento di Scienze chimiche, della Vita e della Sostenibilità ambientale, Università degli Studi di Parma
Margherita Sosio, Naicons, Saronno (VA)
Stefania Stefani, Dipartimento di Scienze biomediche e Biotecnologiche, Università di Catania
Francesca Turroni, Dipartimento di Scienze chimiche, della Vita e della Sostenibilità ambientale, Centro Interdipartimentale “Microbiome Research Hub”, Università degli Studi di Parma
Marco Ventura , Dipartimento di Scienze chimiche, della Vita e della Sostenibilità ambientale, Centro Interdipartimentale “Microbiome Research Hub”, Università degli Studi di Parma
Davide Zannoni, Dipartimento di Farmacia e Biotecnologie, Alma Mater Studiorum Università di Bologna


› 1.1 IL MONDO DEI MICRORGANISMI
Cellula, organismo vivente, microrganismo
Limiti della crescita e riciclo della materia
Unità e diversità del mondo vivente
Procarioti-eucarioti, Bacteria-Archaea
Organismi modello e diversità microbica
› 1.2 COME SI COSTRUISCE UNA CELLULA
Materia-energia-informazione
Dalle molecole semplici alle strutture sopramolecolari
Accrescimento e divisione
› 1.3 DALLA MICROBIOLOGIA
INCONSAPEVOLE ALLA SCOPERTA
DEI MICRORGANISMI
Confutazione della teoria della generazione spontanea
Sviluppo delle tecniche di base per lo studio dei microrganismi
› 1.4 MICRORGANISMI E AMBIENTE
Microrganismi come agenti di malattie e come produttori di farmaci antibatterici
• Scheda 1.1 I postulati di Koch
› 1.5 MICRORGANISMI E TRASFORMAZIONE DELLA SOSTANZA ORGANICA
› 1.6 SVILUPPO DELLA MICROBIOLOGIA COME SCIENZA DI BASE E APPLICATA
• Scheda 1.2 Alcune tappe significative nella storia della microbiologia
› 1.7 AREE SPECIALISTICHE DELLA MICROBIOLOGIA




Che cos’è la vita? Difficile fornire una definizione sintetica ed esaustiva allo stesso tempo, data la complessità di questo fenomeno. Un essere vivente può essere definito come “un sistema in disequilibrio termodinamico con l’ambiente esterno, capace di mantenersi, di riprodursi e di evolvere”. Questo sistema è realizzato attraverso strutture, funzioni e proprietà che accomunano tutto ciò che consideriamo organismo vivente. In questo capitolo introduttivo forniremo un quadro sintetico delle specificità strutturali e funzionali che caratterizzano gli organismi viventi e di come la scoperta e lo studio dei microrganismi abbiano contribuito alla comprensione del fenomeno biologico.
Tutti gli organismi viventi sono costituiti da cellule, le unità strutturali elementari cui possiamo attribuire le proprietà essenziali del vivente. Alcuni organismi sono costituiti da una sola cellula (organismi unicellulari), altri da più cellule solitamente differenziate in tipi diversi (organismi pluricellulari). La maggior parte degli organismi viventi sulla Terra (sia come numero assoluto sia, presumibilmente, come numero di specie) sono unicellulari. Questi, insieme ad alcune classi di organismi pluricellulari, rappresentano i microrganismi. Il nome deriva dal fatto che normalmente questi organismi non sono visibili a occhio nudo. Per osservarne quindi forma e struttura è necessario ricorrere al microscopio ottico



Già a livello morfologico possiamo apprezzare la grande diversità tra cellule: si confronti una cellula dell’epidermide umana con una dell’apice radicale di una pianta, un neurone, un paramecio, un’ifa fungina, una spirocheta (Figura 1.1), solo per citare alcune delle tante tipologie. Ancora più grande può essere la diversificazione funzionale o la collocazione ecologica. Ma per capire “che cos’è la vita” occorre capire ciò che accomuna tutte queste forme prima di considerarne le differenze.
Le cellule hanno innanzitutto una loro identità (Figura 1.2) garantita da un rivestimento, la membrana plasmatica , che le delimita e le isola e allo stesso tempo le mette in comunicazione con l’ambiente esterno. Attraverso la membrana, infatti, la cellula è capace di scambiare molecole con l’esterno in modo selettivo, di percepire le variazioni dell’ambiente circostante e di mettere in atto processi di adattamento che le consentono di mantenere la propria integrità (omeostasi). Tuttavia, nel lungo periodo il mantenimento di una specie cellulare è garantito solo dal fatto che le cellule sono capaci di riprodursi, generando a ogni ciclo due cellule virtualmente identiche alla cellula parentale. Secondo l’assioma di Rudolph Virchow (1858), ogni cellula esistente deriva dalla divisione di un’altra cellula. Una cellula incapace di riprodursi è destinata a scomparire, non fosse altro a causa di eventi accidentali che possono danneggiarne irreparabilmente l’integrità.
L’omeostasi e, a maggior ragione, la riproduzione cellulare richiedono che materiale non cellulare venga importato dall’ambiente esterno nella cellula, elaborato e trasformato in strutture cellulari e infine in nuove cellule. Tutto questo im-




1.1 Confronto tra cellule di specie e di tessuti diversi. (a) Leptospira interrogans
superficie è coperta di ciglia che risultano sfocate a causa del loro rapido movimento. (d) Spirogyra (alga verde) con cloroplasti avvolti (600x). (e) Cellule della foglia di Elodea canadensis; ben visibili i cloroplasti. (40x). (f) Cellule di Purkinje (cervello di ratto; 40x). (g) Epitelio stratificato cuboidale/colonnare visibile in un dotto circondato da tessuto connettivo nella ghiandola parotide. (a), (b), microscopia elettronica a scansione; (c), (f), (g), microscopia ottica; (d), (e), microscopia ottica a contrasto di interferenza differenziale.
La maggior parte dei batteri, esternamente alla membrana plasmatica, possiede una parete. Nonostante la diversa architettura, sia la parete di tipo Gram positivo sia quella di tipo Gram negativo posseggono un’unica enorme molecola polimerica detta sacculo di mureina che avvolge completamente la cellula formando una sorta di esoscheletro cellulare (Figura 2.12).
Il sacculo conferisce alla cellula rigidità e forma, ne protegge l’integrità contrastando la pressione osmotica interna ed è capace di restringere ed espandere il suo volume fino a tre volte senza rompersi sotto una pressione osmotica che può raggiungere a volte le 20 atmosfere. Questa struttura cellulare è essenzialmente costituita da peptidoglicano (detto anche mureina).
Come già accennato (› par. 2.2), nella parete dei batteri Gram positivi è presente un unico spesso strato di peptidoglicano, mentre quella dei Gram negativi presenta una struttura pluristratificata e più complessa che comprende solo un sottile strato di peptidoglicano.
Il peptidoglicano ha una struttura reticolare formata da catene glicaniche costituite da due amminozuccheri alternati, l’N-acetil-glucosammina (NAG) e l’acido N-acetil-muramico (NAM). Al NAM è legato uno stelo tetrapeptidico tramite il quale le catene glicaniche si legano tra loro covalentemente (Figure 2.13 e 2.14) formando un’enorme molecola che avvolge la cellula.
La parete mureinica può essere indebolita o rimossa mediante trattamento con antibiotici che inibiscono la sintesi del peptidoglicano (› Scheda 2.4) o con enzimi specifici che lo degradano, come il lisozima, che catalizza l’idrolisi del legame β-1,4-glicosidico tra gli amminozuccheri del peptidoglicano.

Questi trattamenti possono portare alla lisi osmotica delle cellule se si trovano in un ambiente ipotonico; tuttavia, se le cellule si trovano in un ambiente isotonico (per esempio in una soluzione 0,25 M di saccarosio che, non essendo in grado di entrare nella cellula, bilancia la pressione osmotica intracellulare) si possono ottenere cellule prive di parete dette protoplasti nei batteri Gram positivi o sferoplasti, dotati di membrana esterna, nel caso dei Gram negativi (Figura 2.15). Se i protoplasti e gli sferoplasti sono trasferiti in ambiente ipotonico, questi si rigonfiano per ingresso del solvente fino a lisare. Questi semplici esperimenti evidenziano il ruolo essenziale della parete nel contrastare la pressione osmotica intracellulare e conferire forma e rigidità alla cellula batterica.
N-Acetil-glucosammina (NAG)
Legame β-1,4-glicosidico
Acido N-acetil-muramico (NAM)
1243 Catena tetrapeptidica:
1 = L-Ala (o L-Gly o L-Ser);
2 = D-Glu;
3 = meso-DAP (o L-Lys);
4 = D-Ala
Ponti interpeptidici

Tetrapeptide
Acido N-acetil-muramico (NAM) N-Acetil-glucosammina (NAG)
Gruppo N-acetile
Gruppo lattato
Legame sensibile al lisozima L-Alanina
Acido D-glutammico
Acido meso-diamminopimelico D-Alanina
Figura 2.14 Struttura del glicano tetrapeptide di Escherichia coli, unità ripetuta del peptidoglicano. La struttura è comune a quella di altri batteri Gram negativi, in cui possono essere presenti amminoacidi diversi da quelli mostrati in figura. Il filamento glicanico è costituito da NAM e NAG alternati, legati da legami β-1,4-glicosidici.
Gram positivi
a)
Soluzione ipotonica
Parete
Membrana plasmatica
b)
Soluzione isotonica
Il lisozima digerisce la parete
Entra H2O
Il lisozima digerisce la parete
Protoplasto
Lisi
Membrana plasmatica
Gram negativi
Il lisozima digerisce la parete
Parete mureinica
Entra H2O
Membrana esterna
Il lisozima digerisce la parete
Sferoplasto
Lisi
Figura 2.15 Effetto della distruzione della parete batterica a opera del lisozima. Il lisozima idrolizza il legame β-1,4-glicosidico indebolendo la parete batterica. (a) In una soluzione ipotonica le molecole d’acqua entrano nel citoplasma attraverso la membrana plasmatica semipermeabile. La parete danneggiata non riesce più a contrastare la pressione di turgore causando la lisi cellulare dei batteri sia Gram positivi sia Gram negativi. (b) In una soluzione isotonica, invece, protoplasti e sferoplasti restano intatti e vitali.
I batteri appartenenti al genere Mycobacterium sono caratterizzati dalla presenza di una parete cellulare assolutamente peculiare, insolitamente spessa, ricca di componenti cerose che formano uno spesso strato impermeabile. Ciò rende inutilizzabili le normali colorazioni a base di composti idrofili (inclusa la colorazione di Gram); la colorazione di Ziehl-Neelsen (› Scheda 2.7) permette di colorare in modo differenziale questo importante gruppo di batteri.
La parete dei micobatteri ha una struttura abbastanza complessa (Figura 2.31) che può essere divisa in due strati: lo strato basale (core) costituito da peptidoglicano e arabinogalattano, e una struttura più esterna bistratificata costituita da uno strato di acidi micolici e uno di cere (glicolipidi fenolici).
La disposizione di acidi micolici e cere è tale da formare una vera e propria membrana esterna , strutturalmente e funzionalmente analoga alla membrana esterna dei batteri Gram negativi ma di composizione molto diversa. Anche nella membrana esterna micobatterica sono inserite proteine di diversi tipi e funzioni, tra cui porine che mediano il passaggio di soluti.
Lo strato basale è costituito da un copolimero di peptidoglicano e arabinogalattano. L’arabinogalattano , che rappresenta il maggior polisaccaride di parete, è un polisaccaride ramificato complesso, dove i residui di zuccheri (arabinosio e galattosio) che lo compongono sono presenti in forma furanosica (struttura dell’anello a cinque atomi di
Glicolipidi fenolici (cere)
Acidi micolici
Polisaccaridi (arabinogalattani)
Peptidoglicano
Membrana plasmatica
Lipo-arabinomannano (LAP)
Fosfatidilinositolo mannoside
carbonio) anziché in forma piranosica (a sei atomi di carbonio). Arabinogalattano e peptidoglicano sono uniti tramite legame fosfodiesterico in posizione 6 in circa il 10–12% dei residui di acido muramico.
Gli acidi micolici , che fanno parte del foglietto interno della membrana esterna micobatterica, sono acidi grassi complessi a catena lunga (C60–C90), alchilati e idrossilati. Gli acidi micolici sono ancorati covalentemente alla parete dei batteri (Figura 2.31), contribuendo alla scarsa fluidità della membrana esterna micobatterica.
Nel foglietto esterno troviamo le cere , glicolipidi complessi caratterizzati da catene carboniose molto lunghe e ramificate che interagiscono con gli acidi micolici legandosi a essi in modo non covalente attraverso le porzioni lipidiche. Nella membrana esterna sono presenti anche fosfolipidi.
Questa parete cellulare così complessa, impermeabile e poco fluida, costituisce una barriera protettiva formidabile e rende i micobatteri completamente impermeabili a molte sostanze utilizzate nella terapia medica, compresi molti antibiotici.
Tra gli antibiotici efficaci verso i micobatteri troviamo la rifampicina (› Scheda 11.2), alcuni derivati dell’isoniazide e i benzotiazinoni (› Scheda 2.8).
Da ricordare infine due gruppi di batteri privi di parete mureinica: i micoplasmi, filogeneticamente appartenenti ai Gram positivi (› Scheda 2.9), e le clamidie, appartenenti ai Gram negativi (› Scheda 2.10).
La particolare struttura della parete cellulare conferisce ai batteri del genere Mycobacterium una caratteristica importante per la loro identificazione in microscopia ottica, detta acido-resistenza. I micobatteri infatti sono estremamente difficili da colorare con le consuete tecniche, poiché i coloranti tradizionali, come quelli utilizzati per la colorazione di Gram, non riescono a oltrepassare la barriera impermeabile della loro parete cellulare; d’altra parte, se in condizioni e con coloranti particolari si riesce a imbibire le cellule con un colorante, queste risultano resistenti alla decolorazione.
Verso la fine del secolo XIX Franz Ziehl e Friedrich Neelsen misero a punto un procedimento (noto come colorazione di Ziehl-Neelsen o acido resistente; Figura S2.7-1) con cui colorare in modo irreversibile i micobatteri. Questa colorazione differenziale prevede, in primo luogo, dopo la fissazione al calore del campione su un vetrino da microscopio, un trattamento a caldo dei batteri con una soluzione di fucsina e fenolo in etanolo (detta anche carbolfucsina): a temperatura elevata questo colorante è solubile nei lipidi di parete dei micobatteri e può così penetrare nel citoplasma. Si procede poi con una decolorazione con alcol acido (al 3%) a temperatura ambiente. Questo trattamento non ha effetto sui micobatteri, ma decolora tutti gli altri batteri presenti sul vetrino. Infine si effettua una colorazione di contrasto con blu di metilene, che non viene assorbito dai micobatteri ma colora gli altri batteri presenti nel preparato. Sul vetrino così colorato i micobatteri appaiono come bastoncini rossi (perché non hanno perso la colorazione iniziale della fucsina), mentre altri batteri eventualmente presenti sono colorati in blu.
Micobatteri
Fissazione delle cellule al calore
Carbolfucsina
Trattamento a caldo
Decolorazione con alcol acido
Colorazione di contrasto (blu di metilene)

Figura S2.7-1 Procedimento della colorazione Ziehl-Neelsen. I batteri acido-resistenti appaiono rossi. Le frecce indicano cellule di Mycobacterium tuberculosis dopo la colorazione.
La tubercolosi (TB), nota anche come piaga bianca o white plague, ha rappresentato per millenni una delle principali cause di morte ed è tuttora una delle emergenze sanitarie più importanti soprattutto nei Paesi in via di sviluppo. L’agente patogeno responsabile è Mycobacterium tuberculosis, passato dagli animali alle persone con i primi allevamenti circa 10 000 anni fa. Il picco d’infezione fu raggiunto a cavallo tra il XVIII e il XIX secolo: Robert Koch, scopritore dell’agente causale della malattia (per questo denominato anche bacillo di Koch) scriveva nel 1882 di come la malattia fosse responsabile, ai suoi tempi, di almeno un decesso su sette. Attualmente la mortalità della tubercolosi è stimata in circa 1,3 milioni di decessi l’anno (circa il 16% dei decessi totali), soprattutto nei Paesi emergenti, con circa 10
milioni di nuovi casi per anno e 2 miliardi di portatori del micobatterio in forma latente. M. tuberculosis appartiene alla famiglia delle Mycobacteriaceae e all’ordine Actinomycetales. Ha una complessa parete cellulare cerosa con circa 250 geni dedicati al metabolismo lipidico, con produzione di lunghe catene di acidi micolici ramificati in grado di ridurne la permeabilità: questo ostacola la penetrazione delle molecole esogene, antibiotici compresi (› par. 2.5). Nelle infezioni umane, le cellule di M. tuberculosis sono trasmesse per via aerea, vengono fagocitate dai macrofagi degli alveoli polmonari e si installano nel fagosoma primario, dove iniziano a replicare avendo inibito la fusione con il lisosoma. Il polmone è l’organo bersaglio in cui il patogeno risiede durante l’infezione e durante il periodo di latenza. La TB può permane-
re allo stato latente per decenni, ma si può riattivare in qualsiasi momento. La microaerofilia della popolazione di M. tuberculosis nei polmoni infettati e la bassa permeabilità di questo microrganismo rendono la terapia curativa con antibiotici difficile e lenta. Infatti, mentre una comune infezione batterica richiede dai 10 ai 14 giorni per ottenere la guarigione, la cura della TB può arrivare a 18 mesi. Attualmente una “cura breve” prevede una terapia combinata di almeno 6 mesi; una cura più breve o monoterapica potrebbe portare al fallimento del farmaco e all’insorgenza di batteri resistenti. Per aumentare le possibilità di successo è di fondamentale importanza un’appropriata terapia antibiotica. I pazienti hanno buone probabilità di guarire, tuttavia l’uso dei farmaci antitubercolari, se da un lato riduce la mortalità, dall’altro può
determinare, se applicato in modo improprio, l’aumento dei casi cronici e soprattutto la comparsa di ceppi resistenti.
Diversi sono i farmaci considerati di prima scelta per il trattamento della tubercolosi: rifamicine, isoniazide, pirazinamide, etambutolo, streptomicina, piridomicina e benzotiazinoni. La terapia prevalente prevede l’utilizzo di 4 farmaci (isoniazide, rifamicina pirazinamide ed etambutolo) per 4 mesi e successivamente 2 farmaci (isoniazide e rifamicina) per altri 2 mesi: tale protocollo in presenza di micobatteri sensibili permette il raggiungimento di un tasso di guarigione di circa il 97%.
Le prime rifamicine naturali sono state isolate nel 1958 da brodi di fermentazioni di Amycolatopsis mediterranei come miscela di più componenti. Tra questi, la rifamicina B, attiva su batteri Gram positivi e sui micobatteri, è stata la più studiata: si è osservato infatti che in soluzioni diluite la sua attività aumentava nel tempo, probabilmente a causa di trasformazioni in prodotti più attivi; ciò ha dato inizio a un vasto programma di preparazione e ottimizzazione di rifamicine semisintetiche. La rifamicina e i suoi derivati semisintetici agiscono come inibitori della trascrizione legandosi alla RNA polimerasi batterica. Altri de -
rivati come la rifabutina si sono dimostrati attivi su ceppi resistenti alla rifampicina (› Scheda 11.2).
Gli antibiotici isoniazide, pirazinamide, etambutolo e benzotiazinoni sono di origine sintetica (Figura S2.8-1)
L’ isoniazide ( INH , Isonicotinic Acid Hydrazide) è stata usata per decenni prima che diversi studi ne rivelassero il meccanismo d’azione come farmaco anti-TB; è un pro-farmaco (prodrug), ossia una molecola farmacologicamente inattiva che in vivo viene trasformata in un prodotto attivo. Infatti l’isoniazide deve essere attivata dall’enzima catalasi perossidasi KatG, che, accoppiando il radicale dell’acido isonicotinico in forma esterificata con il NADH, forma un complesso acile-NADH. Questo complesso lega saldamente la enoil-ACP reduttasi, InhA, bloccando di fatto l’azione dell’acido grasso sintasi. Questo processo inibisce la sintesi di acido micolico, necessario per la parete cellulare dei micobatteri.
I benzotiazinoni (BTZ) rappresentano una nuova classe molto promettente di agenti antimicobatterici, capaci di agire anche verso i batteri multiresistenti. Hanno un meccanismo di azione differente da rifampicina e isoniazide. Infatti, legando -
si all’enzima decaprenilfosforil-β-d-ribosio ossidasi (DprE1), coinvolto nella sintesi di arabino-galattano, impediscono la formazione della parete cellulare di M. tuberculosis BTZ043 è un composto di questa classe che ha dimostrato efficacia su modelli animali in vitro e in vivo e si trova attualmente nella fase 2 della ricerca clinica. I BTZ in combinazione con rifampicina o isoniazide mostrano un interessante effetto additivo.
Pirazinamide ed etambutolo sono prodrug impiegati in associazione con rifampicina e isoniazide. In genere vengono utilizzati nei primi mesi di terapia.
Tra gli antibiotici antimicobatterici troviamo anche la piridomicina , un prodotto naturale descritto nel 1953 come agente antitubercolare con una limitata attività verso altri batteri patogeni. È un ciclodepsipeptide contenente residui di 3-(3-piridil)- l -alanina e acido 2-idrossi-3-metilpent-2-enoico. Studi genetici e biochimici hanno dimostrato che agisce inibendo specificamente l’enoil-ACP reduttasi NADH-dipendente InhA, come bersaglio principale. Anche la piridomicina, come l’isoniazide, inibisce la sintesi degli acidi micolici in M. tuberculosis I ceppi di M. tuberculosis resistenti ai singoli farmaci prendono origine da mutazioni spontanee puntiformi nel genoma del micobatterio che si verificano con frequenze basse e prevedibili. Dal momento che non vi è resistenza crociata tra i farmaci comunemente usati, la probabilità che un ceppo sia resistente a due farmaci è bassa, essendo il risultato del prodotto della probabilità di resistenza a ognuno dei farmaci considerati. Ciò nonostante, oltre a ceppi resistenti ai singoli antibiotici come (RR)-TB ( Rifampicin Resistant Tuberculosis ), resistenti a rifampicina, sono emersi anche ceppi con resistenze multiple, come (MDR)-TB (MultiDrug-Resistant), resistenti a rifampicina e isoniazide, e (XDR)-TB ( Extensively Drug-Resistant , estensivamente resistenti), così chiamati perché, oltre a essere (MDR)-TB, hanno sviluppato un’ulteriore resistenza ai fluorochinoloni o ad altri farmaci come amminoglicosidi, amikacina, kanamicina o capreomicina. ANTIBIOTICI
I micoplasmi sono batteri appartenenti alla classe Mollicutes, phylum Tenericutes, e sono divisi in tre ordini: Anaeroplasmatales (generi Anaeroplasma , Asteroleplasma), Acholeplasmatales (genere Acholeplasma ), Mycoplasmatales (generi Mycoplasma, Ureaplasma, Spiroplasma).
Questo particolare gruppo di batteri è incapace di sintetizzare il peptidoglicano ed è pertanto privo di parete. Le cellule dei micoplasmi, quindi, sono racchiuse esclusivamente dalla membrana plasmatica e ricordano molto da vicino i protoplasti. La loro membrana è peculiare: è lipoproteica e ricca di steroli, caso unico fra le cellule batteriche. Queste caratteristiche della membrana rendono i micoplasmi resistenti alla lisi osmotica. Alcuni micoplasmi contengono lipoglicani che sono legati alla membrana e facilitano l’adesione dei batteri alle cellule animali. Le cellule dei micoplasmi sono pleomorfe: possono essere anche molto piccole, filtrabili attraverso membrane con porosità 0,2–0,3 µm, o avere forme filamentose, e si riproducono per gemmazione, frammentazione, scissione binaria. Solitamente sono immobili, tranne alcune specie che possono spostarsi sulle superfici per scivolamento. Molti micoplasmi formano, su terreno agarizzato, colonie piccole e molto particolari che penetrano nell’agar assumendo la classica forma a “uovo fritto” ( Figura S2.9-1a-c ). Per la crescita richiedono terreni ricchi complessi e necessitano, tra l’altro, di colesterolo e acidi grassi a lunga catena oltre che vitamine, precursori di acidi nucleici e amminoacidi. Essendo prive di parete, le cellule risultano negative alla colorazione di Gram; tuttavia filogeneticamente, in base alla sequenza dell’RNA ribosomale 16S, questi batteri risultano essere Gram positivi a basso contenuto G+C (23–46%). Il genoma dei micoplasmi è molto piccolo; ciò è in accordo con le loro elevate richieste nutrizionali, essendo privi di numerose vie biosintetiche. Nel genere Mycoplasma le dimensioni del genoma sono comprese tra 580 e 1350 kb, leggermente maggiori in altri micoplasmi (da 750 a 2200 kb).
I micoplasmi sono tutti commensali, parassiti o patogeni che provocano infezioni croniche e spesso difficili da diagnosticare. Nell’essere umano causano patologie localizzate soprattutto all’apparato respiratorio o genitale, dove si moltiplicano sulla superficie delle mucose. Essendo privi di parete cellulare non sono soggetti all’azione di antibiotici che inibiscono la sintesi del peptidoglicano, come i β-lattamici (penicilline e cefalosporine) e ciò rende più difficile la loro eradicazione.
Il maggior responsabile di patologie respiratorie è Mycoplasma pneumoniae , una delle principali cause della polmonite atipica primaria, forma più grave e frequente di polmonite dopo quella causata da Streptococcus pneumoniae che, a causa della mancanza del peptidoglicano, non può essere trattata con gli antibiotici β -lattamici. Sono commensali M. salivarium, M. orale, M. buccale, M. faecium e

M. lipophilum . Tra i micoplasmi che danno patologie a livello genitale e urinario si trovano con maggior frequenza M. hominis e, più raramente, M. genitalium , M. fermentans , M. spermatophilum e M. primatum
Si conosce anche un gruppo di micoplasmi opportunisti che manifestano la loro patogenicità a livello genitale su individui affetti da HIV come M. penetrans, che ha la caratteristica di penetrare nell’epitelio mucoso (diversamente dagli altri) e moltiplicarvisi.
Altri generi inclusi nell’ordine Mycoplasmatales sono Spiroplasma ( Figura
S2.9-1d), dalla caratteristica forma a cavatappi (comprese specie patogene per piante e insetti), e Ureaplasma, tra cui U. urealyticum, il cui nome deriva dalla sua capacità di scindere, per via enzimatica, l’urea (a volte associato a infezioni del tratto urinario).





Il virione è la forma extracellulare della particella virale completa, dotata di capacità infettiva. Questa particella è costituita dal genoma circondato da un involucro proteico protettivo, il capside
L’osservazione al microscopio elettronico evidenzia l’ampia diversità di forme e strutture dei virioni: dai più semplici, che comprendono una singola molecola di acido nucleico e un solo tipo di proteina strutturale, fino ai più complessi, formati da molte proteine diverse e da altri componenti (Figura 14.1). Le loro dimensioni variano, di norma, tra i 20 e i 400 nm. In alcuni di essi il nucleocapside, ovvero l’insieme del genoma e delle proteine del capside, è contenuto all’interno di un ulteriore involucro, detto pericapside o envelope. I virus con envelope sono detti virus rivestiti, mentre i virus che non lo presentano sono anche chiamati virus nudi (Figura 14.2).
14.1.1
I genomi virali sono decisamente più diversificati, per composizione, struttura, dimensione e potere codificante, di quelli degli organismi cellulari procarioti ed eucarioti. In pratica, nei virus è possibile riscontrare qualsiasi configurazione molecolare in grado di codificare informazioni in un acido nucleico. Infatti, il genoma virale può essere costituito da DNA, RNA, oppure DNA con piccoli segmenti di RNA, e l’acido nucleico può a volte essere legato in modo covalente a proteine.
L’acido nucleico virale può essere a doppia elica (dsDNA, dsRNA), parzialmente a doppia elica ( gapped ), oppure a singola elica (ssDNA, ssRNA), con polarità positiva (+), ossia costituito dall’elica codificante, con polarità negativa (‒), ossia costituito dall’elica complementare, oppure con polarità diversa in tratti genomici diversi. Il genoma virale, infine, può essere lineare o circolare, costituito da un’unica molecola o
suddiviso in più molecole (segmentato). Il numero di geni codificati da un genoma virale varia da meno di una decina fino a diverse centinaia.
Questa grande diversità può permettere alcune considerazioni. Innanzitutto, quale significato può avere? Sebbene sia evidente che la natura di un genoma si riflette sulle strategie replicative dei virus, si hanno pochi elementi su eventuali vantaggi selettivi di un tipo di genoma rispetto a un altro.
Perché esistono virus con genoma a DNA e virus con genoma a RNA? Anche in questo caso non vi sono risposte certe, anche se si ritiene che i genomi di alcuni virus a RNA possano essere reliquie molecolari di un mondo antico in cui l’RNA era l’unica molecola depositaria dell’informazione genetica che, contemporaneamente, possedeva attività catalitica (RNA world ). A quel tempo, miliardi di anni fa, sarebbero coevoluti i primi organismi cellulari, con genoma a RNA, e virus a RNA. In seguito, l’evoluzione della vita cellulare verso una forma con materiale genetico a DNA si sarebbe accompagnata all’evoluzione dei virus a DNA. I virus con genomi a RNA che si sono dimostrati più competitivi dal punto di vista evolutivo avrebbero continuato a coevolvere con i loro ospiti fino a oggi.
Esiste inoltre una qualche relazione tra tipo di genoma e specificità di ospite? Anche per questo aspetto non vi sono regole definitive. In generale, i genomi a RNA sono più diffusi tra i virus vegetali, sebbene si conoscano diversi virus delle piante a DNA, per esempio i Geminiviridae e i Caulimoviridae. Negli animali, molti virus a RNA tendono a diffondersi e passare a ospiti di specie diverse compiendo il cosiddetto “salto di specie”, come si è osservato per i coronavirus, mentre i virus animali a DNA tendono a essere più speciespecifici per gli ospiti in cui si replicano.
Non vi sono invece dubbi sul fatto che l’assetto biosintetico delle cellule ospiti, basato su sistemi genetici a DNA, condizioni le strategie molecolari che virus con genoma a DNA o
Capside proteico icosaedrico composto da capsomeri
Figura 14.2 Strutture di virioni nudi e rivestiti.
Virione nudo con capside icosaedrico (es. Adenovirus)
Subunità strutturali
Capside proteico elicoidale
Virione nudo con capside elicoidale (es. TMV)
a RNA hanno sviluppato per l’espressione e la replicazione del proprio genoma. Per i virus a DNA, queste sintesi possono, a prima vista, apparire facilitate dalla presenza di sistemi enzimatici evoluti per la trascrizione e duplicazione del DNA cellulare, che quindi possono essere semplicemente utilizzati dal virus. Al contrario, le cellule ospiti, siano esse vegetali o animali, non hanno RNA polimerasi RNAdipendenti in grado di replicare i genomi dei virus a RNA o di sintetizzare un mRNA impiegando come stampo un altro RNA. Queste funzioni devono quindi essere espletate da RNA polimerasi RNAd ipendenti codificate dagli stessi virus. L’mRNA prodotto può così essere tradotto dai ribosomi dell’ospite. Un’importante eccezione a questa regola è rappresentata dai retrovirus, virus a ssRNA che producono mRNA a partire da una forma intermedia del loro ciclo replicativo costituita da dsDNA, il cosiddetto provirus , che viene trascritto dall’RNA polimerasi II dell’ospite.
In che forma i genomi virali sono contenuti nei capsidi? Generalmente, virus con piccoli genomi, sia a RNA sia a DNA, liberano nella cellula infettata il loro acido nucleico come molecola nuda; con l’aumentare delle dimensioni dei genomi, o con la loro segmentazione, si osserva l’associazione con specifiche proteine virali in grado di interagire e legare gli acidi nucleici. Tuttavia, nonostante la presenza di proteine virali associate con il genoma, non si osserva mai, tranne nel caso
Virione rivestito con capside icosaedrico (es. Herpesvirus)
Envelope
Capside proteico icosaedrico
Envelope
Acido nucleico
Capside proteico elicoidale
Virione rivestito con capside elicoidale (es. Paramyxovirus)
dei Polyomaviridae, la presenza di istoni complessati con gli acidi nucleici virali. La configurazione dei genomi virali può poi essere molto complessa per la loro capacità di ripiegarsi in strutture secondarie e terziarie alquanto caratteristiche e funzionalmente importanti; infatti, le sequenze e le strutture presenti alle estremità di alcuni genomi virali spesso sono indispensabili per le fasi di replicazione, di sintesi degli mRNA, di traduzione delle proteine e di impaccamento degli acidi nucleici nei virioni.
Infine, vi sono limiti alle dimensioni dei genomi virali? In genere, i virus a DNA presentano una maggiore variabilità nelle dimensioni con limiti che variano da poche kb (come nel caso del genoma circolare a singola elica di DNA di 1,7‒2,3 kb dei Circoviridae) fino a diverse centinaia di kb (come nel caso dei Mimivirus che infettano alcuni protozoi e che hanno un genoma di 1200 kb). Al contrario, i genomi dei virus a RNA sono piuttosto piccoli, con dimensioni massime intorno a 30 kb, per esempio il genoma dei coronavirus umani, tra cui SARS CoV2.
Da quanto detto sulla diversità dei genomi virali, è evidente che i virus costituiscono un raggruppamento eterogeneo dal punto di vista evolutivo di elementi genetici accomunati solo dalla capacità di codificare proteine che permettono la costruzione di strutture extracellulari in grado di consentirne la propagazione mediante l’infezione di nuove cellule.



Un lavoro pubblicato sulla rivista Science nel 1995 ha inaugurato un nuovo modo di studiare i microrganismi, soprattutto i procarioti. L’articolo riportava per la prima volta la sequenza nucleotidica dell’intero genoma di un organismo cellulare, il batterio Haemophilus influenzae (Figura 17.1). Da allora il numero di ceppi microbici i cui genomi sono stati interamente sequenziati è aumentato in modo esponenziale, grazie agli sforzi sempre maggiori da parte dei gruppi di ricerca interessati e allo sviluppo di tecniche di sequenziamento e di analisi delle sequenze sempre più potenti (Figura 17.2).
L’alto numero di genomi microbici sequenziati ha portato a importanti nuove interpretazioni dell’evoluzione e del concetto di specie nei procarioti (› Capitoli 8 e 18). Per esempio, la genomica ci ha permesso di capire come ceppi all’interno della stessa specie possano differire notevolmente tra loro per una parte del loro contenuto genico e come queste differenze possano spiegare la loro diversa natura (per esempio ceppi patogeni e non patogeni della stessa specie). Per tener conto di queste differenze è stato introdotto un nuovo concetto, quello di pangenoma , a cui appartengono i geni condivisi all’in-

Figura 17.1 Mappa della sequenza completa del genoma di Haemophilus influenzae ceppo Rd. La figura, apparsa sulla copertina della rivista Science nel luglio del 1995, mostra la localizzazione delle 1737 ORF predette sul genoma circolare composto da 1 830 137 coppie di basi. Sul perimetro esterno sono riportate le coordinate (in pdb) della sequenza e la posizione dei siti di riconoscimento di tre enzimi di restrizione (NotI, RsrII e SmaI). Il cerchio esterno indica le regioni codificanti per ORF, colorate in base alla loro funzione. Il secondo cerchio indica con colori diversi le regioni con alto e basso contenuto in G+C (rispettivamente rosse e blu) e le regioni ricche in A+T (rispettivamente nere e verdi). Il terzo cerchio indica la posizione dei sei operoni ribosomali (in verde), dei tRNA (in nero) e di un profago (in blu). Il quarto cerchio indica la posizione delle ripetizioni in tandem. L’origine di replicazione è evidenziata da due frecce in verde divergenti da un punto vicino alla base 603 000. Due presunti siti di terminazione della replicazione sono indicati dall’altra parte del cerchio in rosso
Figura 17.2 Sequenze genomiche depositate nella banca dati GenBank. La banca dati pubblica GenBank contiene attualmente 2,3 miliardi di sequenze genomiche con un aumento esponenziale negli anni di sequenze depositate. Se le sequenze batteriche hanno rappresentato per molti anni il numero maggiore di sequenze genomiche depositate, negli ultimi anni, grazie alle moderne metodiche di sequenziamento, il maggior incremento è rappresentato da sequenze animali, incluse sequenze umane. Negli anni 20202023 l’incremento maggiore è stato rappresentato da sequenze virali durante l’epidemia di virus SARS-CoV-2 con 1,5 milioni di genomi virali interi depositati.
terno di una stessa specie (genoma condiviso o core genome), mentre le sequenze e i geni che si ritrovano solo in una frazione dei ceppi di una stessa specie prendono il nome di genoma accessorio o accessory genome (› par. 17.1.3).
17.1.1 Sequenziamento di genomi procarioti
Il sequenziamento di interi genomi di procarioti (Figura 17.2) è diventato un obiettivo relativamente facile da conseguire, specialmente dopo lo sviluppo di tecnologie di sequenziamento del DNA estremamente potenti, ad alta resa e completamente automatiche, avvenuto negli ultimi dieci anni. Attualmente, la mera decifrazione dell’intera sequenza nucleotidica di un genoma batterico di media grandezza può essere realizzata, in un laboratorio opportunamente attrezzato, in poche ore con costi relativamente contenuti.
I sequenziatori di DNA di nuova generazione, infatti, applicando tecnologie di miniaturizzazione e di robotizzazione altamente sofisticate, hanno apportato una nuova rivoluzione nei progetti di sequenziamento genomico. L’uso di queste macchine ha infatti ridotto in modo impressionante i tempi e i costi del sequenziamento. Nella Tabella 17.1 sono riassunte alcune delle caratteristiche di tre piattaforme di sequenziamento di nuova generazione (il cosiddetto Next Generation Sequencing, NGS).
Come si vede chiaramente dai dati riportati, il sequenziamento con macchine di ultima generazione può produrre frammenti di sequenza sia molto corti sia molto lunghi (per esempio con le tecnologie Pacific Biosciences e Oxford Nanopore), con i quali è virtualmente possibile assemblare in modo automatico un intero genoma procariote, cioè ricostruirne l’intera sequenza completa del cromosoma e degli even-
Piattaforma Lunghezza media del frammento sequenziato (basi) Basi sequenziate per processo (giga basi) Accuratezza
(strumentazione MiSeq)
(strumentazione NextSeq)
Alta accuratezza; elevato numero di basi sequenziate Pacific Bioscience (strumento Revio)
Nanopore (strumentazione MinION)
tuali elementi plasmidici accessori. Va anche ricordato che lo sviluppo tecnologico in questo campo è così rapido da far prevedere che, nel giro di pochi anni, gli strumenti disponibili renderanno sempre più veloce e accessibile il sequenziamento di interi genomi.
Qualsiasi sia la tecnica utilizzata per il sequenziamento di un intero genoma, la sua qualità è definita da alcuni importanti parametri. In particolare:
1. la completezza , cioè l’assenza di parti non sequenziate. Questo parametro è più facilmente rispettato per i procarioti che per gli eucarioti, date le dimensioni più piccole dei loro genomi e la ridotta presenza di sequenze ripetute;
2. l’accuratezza , un parametro statistico che stima quanto la sequenza di DNA ottenuta sia prossima a quella reale. Questa dipende da diversi fattori, come la qualità dei sequenziatori, il numero di “letture” ottenute per ogni tratto di sequenza, il numero di sequenze ambigue (basi non assegnate con certezza);
3. la corrispondenza della struttura ricostruita montando in modo ordinato i blocchi contigui di sequenze (contig) con la struttura effettiva del cromosoma. La corrispondenza può essere validata confrontando la sequenza ricostruita con la struttura cromosomica ottenuta con altri mezzi, quali le mappe genetiche e le mappe di restrizione.
I genomi sequenziati sono in generale di pubblico dominio e sono accessibili tramite Internet in alcune banche dati, quali la statunitense Genbank, l’European Nucleotide Archive (ENA) e la DNA Data Bank of Japan (DDBJ). Queste banche dati sincronizzano giornalmente tra loro tutte le sequenze depositate per garantire un accesso stabile e globale ai dati raccolti. Visto l’esponenziale incremento delle informazioni genetiche e genomiche disponibili, le interfacce telematiche e bioinformatiche tra gli utenti e queste banche sono in continuo sviluppo.
Una sequenza di basi azotate anche breve non ha senso immediato se non viene interpretata, e quindi l’intera sequenza genomica di un microrganismo per essere utilizzata deve anche essere “annotata”. “Annotare un genoma” significa identificare i singoli pezzi di sequenza che hanno una funzione e attribuire a essi la funzione stessa. In particolare si identifi-
lunge di singole molecole
Sequenze lunge; piccolo strumento portatile
cano: sequenze che possono potenzialmente codificare per le proteine (ORF, Open Reading Frame), sequenze codificanti gli RNA (messaggeri, ribosomali, transfer, RNA non codificanti), sequenze regolative e sequenze ripetute. La parte più facile dell’annotazione è rappresentata dall’assegnazione di una funzione ai geni che codificano per proteine. Questo processo viene effettuato in modo automatico da vari programmi accessibili online. Sulla base delle conoscenze acquisite, soprattutto sulla funzione di geni conservati e/o caratterizzati in organismi modello, il processo è in grado di assegnare una funzione a più del 70% dei geni codificanti proteine di un genoma batterico, mentre i geni rimanenti vengono annotati come “ hypothetical protein”, cioè geni codificanti proteine ma con funzione non attribuibile. L’integrazione di informazioni provenienti da centinaia di migliaia di genomi sta contribuendo a migliorare molto la qualità dell’annotazione automatizzata, riducendo sempre di più il numero di geni annotati come “ hypothetical protein”. È più difficile l’identificazione delle regioni regolatorie e dei geni non codificanti proteine, come gli RNA non codificanti (ncRNA, noncoding RNA). Questo lavoro richiede spesso l’integrazione di dati sperimentali per verificare l’effettiva presenza di RNA individuata tramite sequenziamento dell’RNA. Anche dopo aver identificato sperimentalmente trascritti verosimilmente non codificanti per proteine (ncRNA, RNA con codoni di stop in tutti i reading frame), la loro funzione specifica rimane spesso incerta.
L’assegnazione di una funzione a una potenziale proteina, quando questa non fosse già nota da studi precedenti, parte sempre dalla ricerca di sequenze simili (omologhe) già identificate in genomi di altri organismi. La bioinformatica ha sviluppato numerosi programmi molto sofisticati per l’analisi delle somiglianze tra le sequenze geniche. Senza entrare in dettagli che esulano dagli scopi di questo capitolo, bisogna ricordare che tutte le sequenze di DNA e di proteine conosciute e depositate nelle banche dati pubbliche sono confrontabili tra loro per verificarne la similarità. Quest’analisi può essere effettuata mediante uno strumento informatico liberamente accessibile su Internet denominato BLAST (Basic Local Alignment Search Tool, www.ncbi.nlm.nih.gov/BLAST). In pratica questo programma individua tutte le sequenze che presentano una similarità con una sequenza di “interrogazione” (query sequence) proposta dall’utente (Figura 17.3).


› 19.1 DALLA POPOLAZIONE ALL’ECOSISTEMA
MICROBICO
• Scheda 19.1 Un approccio operativo per descrivere le comunità microbiche
› 19.2 PROCESSI ECOLOGICI
Comunità microbiche versus comunità di macrorganismi
Sintesi concettuale dell’ecologia delle comunità microbiche
› 19.3 HABITAT MICROBICI TERRESTRI
Microbioma del suolo
Effetto del microbioma sulla struttura e proprietà del suolo
Legame tra struttura e funzioni nel microbioma del suolo
› 19.4 HABITAT MICROBICI MARINI
Zona pelagica
Oceano profondo
Sedimenti marini

I microrganismi sono ampiamente stati studiati come entità isolate, utilizzando la coltura pura per analizzarne le proprietà specifiche. Questo metodo ha permesso di comprendere molte caratteristiche fondamentali dei singoli microrganismi, ma offre una visione limitata della loro complessità.
In questa sezione del testo sposteremo la nostra attenzione sull’analisi dei microrganismi nel loro ambiente naturale. Questo approccio non considera solo il microrganismo in sé ma anche le sue interazioni con l’ambiente abiotico e con altri microrganismi. Tali interazioni, come la competizione, la simbiosi o la formazione di comunità complesse, sono essenziali per capire il comportamento e il ruolo ecologico dei microrganismi. Studiarli nel loro contesto naturale offre una comprensione più completa delle loro dinamiche e del loro impatto sugli ecosistemi. I termini “microbiologia ambientale” ed “ecologia microbica” vengono spesso utilizzati come sinonimi. Essi
Microhabitat marini: la neve marina e la ficosfera
• Scheda 19.2 I batteri ubiquitari Synechococcus, Prochlorococcus e SAR11
› 19.5 HABITAT ESTREMI
Sorgenti geotermali terrestri
Sorgenti idrotermali marine profonde
Criosfera
Ambienti ipersalini
Drenaggio acido delle miniere
Altri ambienti estremi
• Scheda 19.3 Limiti chimico-fisici della vita microbica sulla Terra e proiezione su altri pianeti
• Scheda 19.4 La biogeoalbedo
› 19.6 HABITAT ANTROPIZZATI E COSTRUITI
Habitat microbici urbani
Microbiologia applicata all’ambiente e alla transizione energetica
presentano infatti connotazioni comuni, anche se sottendono concetti con alcune lievi differenze. La microbiologia ambientale studia i processi ambientali mediati dai microrganismi e, conseguentemente, considera aspetti sia generali, legati al funzionamento degli ecosistemi e ai cicli biogeochimici, sia di tipo applicativo, quali quelli legati al trattamento delle acque reflue o al biorisanamento di ambienti contaminati. L’ecologia microbica approfondisce le tematiche relative ai processi che definiscono la struttura e le funzioni delle comunità microbiche negli ambienti, naturali o artificiali, e in associazione con macrorganismi. Essa studia quindi le reciproche interazioni tra i microrganismi e il resto della componente biotica e l’ambiente, e come queste interazioni definiscono la composizione delle comunità e le funzioni ecosistemiche, ovvero l’insieme dei processi e delle attività svolti dagli organismi che contribuiscono al mantenimento e alla regolazione del funzionamento
dell’ecosistema. L’ecologia microbica cerca di sviluppare modelli ecologici predittivi che descrivano la struttura e le funzioni delle comunità microbiche, il loro adattamento alle condizioni ambientali e la loro evoluzione nel tempo. In questo capitolo verranno presentati alcuni principi generali di ecologia microbica e verranno descritte le caratteristiche di ecosistemi e habitat microbici, integrando aspetti di ecologia microbica e microbiologia ambientale.
Il concetto di “popolazione” è centrale nei campi dell’ecologia, della biologia evolutiva e della biologia della conservazione, e in letteratura si possono trovare numerose definizioni. In genere, queste si basano su descrizioni qualitative come «un gruppo di organismi della stessa specie che occupa uno spazio in un tempo definito». Per i microrganismi il termine “popolazione” è particolarmente complesso da definire a causa dell’assenza di un concetto di specie biologicamente significativo per i procarioti. Per ovviare alla genericità della definizione di popolazione microbica quale rappresentante locale di una specie e renderla operativa negli studi di ecologia microbica e microbiologia ambientale, si utilizzano unità tassonomiche arbitrarie per misurare la composizione delle comunità. Queste unità, approfondite nella › Scheda 19.1, si basano principalmente sull’analisi delle sequenze di geni marcatori della filogenesi, quali i geni codificanti per le subunità piccole del ribosoma (SSU, Small SubUnit) (› Capitolo 18), e degli spaziatori trascritti interni (ITS, Internal Transcribed Spacer), e sono quindi anche identificate come filotipi. In alcuni studi il concetto di popolazione microbica si estende anche all’aspetto funzionale (per esempio popolazione di metanotrofi).
Organismi appartenenti alla medesima popolazione condividono caratteristiche genetiche simili e interagiscono tra loro in vari modi, tra cui la competizione per le risorse e la cooperazione per la sopravvivenza. La dimensione di una popolazione microbica può variare enormemente in base a fattori ambientali come disponibilità di nutrienti, condizioni di temperatura e pH, e presenza di sostanze tossiche o di altri microrganismi.
Le dinamiche di una popolazione microbica possono essere influenzate dai tassi di duplicazione, morte e trasferimento spaziale, oltre che da mutazioni e scambi genetici.
Una comunità microbica è un insieme complesso di diverse popolazioni microbiche che coesistono in uno stesso ambiente. Queste comunità possono essere estremamente variabili, da quelle semplici composte da poche popolazioni a quelle molto complesse con migliaia di popolazioni diverse. La composizione di una comunità microbica è influenzata non solo dalle condizioni ambientali ma anche dalle interazioni tra le popolazioni, che possono includere competizione, predazione, simbiosi e mutualismo. Tra i parametri che descrivono
le caratteristiche di una popolazione, distinguiamo tra l’abbondanza assoluta di individui che la compongono, espressa come numero di individui o un suo equivalente rispetto al peso o al volume della matrice ambientale (per esempio ufc/mL, g di biomassa/L, numero di copie di geni/g di suolo) e l’abbondanza relativa di una popolazione microbica, definita come proporzione della popolazione rispetto al totale della comunità. La struttura di una comunità microbica si definisce in base alla presenza e all’abbondanza relativa delle popolazioni microbiche o delle unità tassonomiche considerate che la compongono. Anche la struttura è influenzata da una varietà di fattori, tra cui risorse disponibili, condizioni ambientali e interazioni tra taxa microbici. La comprensione della struttura di una comunità microbica è fondamentale per prevedere come le comunità rispondano ai cambiamenti ambientali e per capire il loro ruolo nei cicli biogeochimici. Un aspetto chiave che caratterizza una comunità microbica è la diversità, che si declina principalmente in diversità α e β.
La diversità α considera la diversità delle popolazioni all’interno di una comunità microbica. Essa si articola in due componenti principali: la ricchezza in popolazioni e l’uniformità di distribuzione delle loro abbondanze. La ricchezza in popolazioni microbiche si riferisce al numero totale di popolazioni diverse presenti nella comunità. Una maggiore ricchezza di questo tipo indica una varietà più ampia di organismi e può essere un indicatore della salute di un ecosistema. Come si vedrà successivamente, in un habitat che contiene diversi microambienti, un’elevata ricchezza può supportare un’alta resilienza e stabilità dell’ecosistema. Tuttavia, la ricchezza da sola non fornisce un quadro completo della diversità α, poiché non tiene conto dell’abbondanza relativa delle diverse popolazioni.
L’uniformità (evenness) descrive come le abbondanze delle diverse popolazioni sono distribuite all’interno della comunità. L’uniformità di una comunità è elevata quando le diverse popolazioni sono presenti in proporzioni simili, nessuna popolazione è dominante e c’è un bilanciamento tra quelle presenti. Al contrario, una condizione di bassa uniformità si verifica quando una o poche popolazioni sono molto più abbondanti delle altre, indicando potenzialmente condizioni ambientali che favoriscono queste rispetto ad altre. Per la misura e la stima della diversità α si veda la › Scheda 19.1
La diversità β descrive il grado di differenza tra le strutture di comunità microbiche in due o più ambienti diversi o habitat. Essa è una misura della variazione nella composizione tra comunità e può essere analizzata in termini di presenza/ assenza delle unità tassonomiche considerate e delle loro abbondanze relative o assolute. Questo concetto è fondamentale per comprendere come i microrganismi si distribuiscono nei diversi ambienti e come rispondono ai cambiamenti ambientali. La diversità β può essere definita in funzione unicamente della presenza/assenza delle unità tassonomiche considerate nelle comunità che si prendono in esame. Se due comunità condividono molte unità tassonomiche, la loro diversità β è bassa. Al contrario, se hanno poche o nessuna unità tassono-
© 2026 CEA - Casa Editrice Ambrosiana, viale Romagna 5, 20089 Rozzano (MI) [69956]
CEA - Casa Editrice Ambrosiana è un marchio editoriale di Zanichelli editore S.p.A.
Le edizioni precedenti sono state curate da Gianni Deho ed Enrica Galli.
Diritti riservati
I diritti di pubblicazione, riproduzione, comunicazione, distribuzione, trascrizione, traduzione, noleggio, prestito, esecuzione, elaborazione in qualsiasi forma o opera, di memorizzazione anche digitale e di adattamento totale o parziale su supporti di qualsiasi tipo e con qualsiasi mezzo (comprese le copie digitali e fotostatiche), sono riservati per tutti i paesi. L’acquisto della presente copia dell’opera non implica il trasferimento dei suddetti diritti né li esaurisce.
Fotocopie e permessi di riproduzione
Le fotocopie per uso personale (cioè privato e individuale, con esclusione quindi di strumenti di uso collettivo) possono essere effettuate, nei limiti del 15% di ciascun volume, dietro pagamento alla S.I.A.E. del compenso previsto dall’art. 68, commi 4 e 5, della legge 22 aprile 1941 n. 633. Tali fotocopie possono essere effettuate negli esercizi commerciali convenzionati S.I.A.E. o con altre modalità indicate da S.I.A.E.
Per le riproduzioni ad uso non personale (ad esempio: professionale, economico, commerciale, strumenti di studio collettivi, come dispense e simili) l’editore potrà concedere a pagamento l’autorizzazione a riprodurre un numero di pagine non superiore al 15% delle pagine del presente volume.
Le richieste vanno inoltrate a: Centro Licenze e Autorizzazioni per le Riproduzioni Editoriali (CLEARedi), Corso di Porta Romana 108, 20122 Milano e-mail: autorizzazioni@clearedi.org e sito web: www.clearedi.org
L’autorizzazione non è concessa per un limitato numero di opere di carattere didattico riprodotte nell’elenco che si trova all’indirizzo www.zanichelli.it/chi-siamo/fotocopie-e-permessi
L’editore, per quanto di propria spettanza, considera rare le opere fuori del proprio catalogo editoriale. La loro fotocopia per i soli esemplari esistenti nelle biblioteche è consentita, anche oltre il limite del 15%, non essendo concorrenziale all’opera. Non possono considerarsi rare le opere di cui esiste, nel catalogo dell’editore, una successiva edizione, né le opere presenti in cataloghi di altri editori o le opere antologiche. Nei contratti di cessione è esclusa, per biblioteche, istituti di istruzione, musei e archivi, la facoltà di cui all’art. 71-ter legge diritto d’autore. Per permessi di riproduzione, diversi dalle fotocopie, rivolgersi a ufficiocontratti@zanichelli.it
Licenze per riassunto, citazione e riproduzione parziale a uso didattico con mezzi digitali La citazione, la riproduzione e il riassunto, se fatti con mezzi digitali, sono consentiti (art. 70 bis legge sul diritto d’autore), limitatamente a brani o parti di opera, a) esclusivamente per finalità illustrative a uso didattico, nei limiti di quanto giustificato dallo scopo non commerciale perseguito. (La finalità illustrativa si consegue con esempi, chiarimenti, commenti, spiegazioni, domande, nel corso di una lezione); b) sotto la responsabilità di un istituto di istruzione, nei suoi locali o in altro luogo o in un ambiente elettronico sicuro, accessibili solo al personale docente di
Redazione e indice analitico: Gabriella Piazza
Impaginazione: Claudia Angela Capelli; Edistudio, Milano
tale istituto e agli alunni o studenti iscritti al corso di studi in cui le parti di opere sono utilizzate; c) a condizione che, per i materiali educativi, non siano disponibili sul mercato licenze volontarie che autorizzano tali usi.
Zanichelli offre al mercato due tipi di licenze di durata limitata all’anno accademico in cui le licenze sono concesse:
A) licenze gratuite per la riproduzione, citazione o riassunto di una parte di opera non superiore al 5%. Non è consentito superare tale limite del 5% attraverso una pluralità di licenze gratuite, B) licenze a pagamento per la riproduzione, citazione, riassunto parziale ma superiore al 5% e comunque inferiore al 40% dell’opera. Per usufruire di tali licenze occorre seguire le istruzioni su www.zanichelli.it/licenzeeducative
L’autorizzazione è strettamente riservata all’istituto educativo licenziatario e non è trasferibile in alcun modo e a qualsiasi titolo.
Garanzie relative alle risorse digitali
Le risorse digitali di questo volume sono riservate a chi acquista un volume nuovo: vedi anche al sito www.zanichelli.it/contatti/acquisti-e-recesso le voci Informazioni generali su risorse collegate a libri cartacei e Risorse digitali e libri non nuovi Zanichelli garantisce direttamente all’acquirente la piena funzionalità di tali risorse. In caso di malfunzionamento rivolgersi a assistenza@zanichelli.it
La garanzia di aggiornamento è limitata alla correzione degli errori e all’eliminazione di malfunzionamenti presenti al momento della creazione dell’opera. Zanichelli garantisce inoltre che le risorse digitali di questo volume sotto il suo controllo saranno accessibili, a partire dall’acquisto, per tutta la durata della normale utilizzazione didattica dell’opera. Passato questo periodo, alcune o tutte le risorse potrebbero non essere più accessibili o disponibili: per maggiori informazioni, leggi my.zanichelli.it/fuoricatalogo
Soluzioni degli esercizi e altri svolgimenti di compiti assegnati
Le soluzioni degli esercizi, compresi i passaggi che portano ai risultati e gli altri svolgimenti di compiti assegnati, sono tutelate dalla legge sul diritto d’autore in quanto elaborazioni di esercizi a loro volta considerati opere creative tutelate, e pertanto non possono essere diffuse, comunicate a terzi e/o utilizzate economicamente, se non a fini esclusivi di attività didattica.
Diritto di TDM
L’estrazione di dati da questa opera o da parti di essa e le attività connesse non sono consentite, salvi i casi di utilizzazioni libere ammessi dalla legge. L’editore può concedere una licenza. La richiesta va indirizzata a tdm@zanichelli.it
Intelligenza artificiale e copyright Nessuna parte di questo libro, incluse le espansioni digitali, può essere immessa in sistemi di intelligenza artificiale (siano essi chatbot o piattaforme che utilizzano l’IA per la creazione di materiali didattici o di altro tipo) senza il consenso scritto dell’editore.
Disegni: Giuseppe Maserati (derivati dalle precedenti edizioni), Daniele Gianni (nuovi)
Copertina:
– Progetto grafico: Falcinelli & Co., Roma
– Immagine di copertina: © P.A. McTurk, University of Leicester, & David Parker/Science Photo Library
Prima edizione: gennaio 2012
Seconda edizione: settembre 2014
Terza edizione: dicembre 2018
Quarta edizione: gennaio 2026
Ristampa: prima tiratura 5 4 3 2 1 2026 2027 2028 2029 2030
Realizzare un libro è un’operazione complessa, che richiede numerosi controlli: sul testo, sulle immagini e sulle relazioni che si stabiliscono tra essi. L’esperienza suggerisce che è praticamente impossibile pubblicare un libro privo di errori. Saremo quindi grati ai lettori che vorranno segnalarceli.
Per segnalazioni o suggerimenti relativi a questo libro scrivere al seguente indirizzo: Zanichelli editore S.p.A. Via Irnerio 34 40126 Bologna fax 051293322
e-mail: linea_universitaria@zanichelli.it sito web: www.zanichelli.it
Prima di effettuare una segnalazione è possibile verificare se questa sia già stata inviata in precedenza, identificando il libro interessato all’interno del nostro catalogo online per l’Università.
Per comunicazioni di tipo commerciale: universita@zanichelli.it
Stampa:
per conto di Zanichelli editore S.p.A. Via Irnerio 34, 40126 Bologna
Paolo Landini Marco Ventura
Quarta edizione
Inquadra e scopri i contenuti
Le risorse digitali universita.zanichelli.it/deho4e
A questo indirizzo sono disponibili le risorse digitali di complemento al libro. Per accedere alle risorse protette è necessario registrarsi su my.zanichelli.it inserendo il codice di attivazione personale contenuto nel libro.
Libro con Ebook Chi acquista il libro nuovo può accedere gratuitamente all’Ebook, seguendo le istruzioni presenti nel sito.
L’accesso all’Ebook e alle risorse digitali protette è personale, non condivisibile e non cedibile, né autonomamente né con la cessione del libro cartaceo.
Biologia dei microrganismi illustra struttura, funzione ed evoluzione dei microrganismi approfondendo i meccanismi molecolari, genetici ed ecologici che ne governano la vita nei diversi ambienti. È un testo in grado di connettere aspetti teorici e applicativi, che spaziano dalla biologia cellulare alla genomica, dalla microbiologia ambientale alla patogenesi batterica. Utilizzando un linguaggio scientifico rigoroso e con il supporto di esempi concreti, affronta sia temi cruciali, come i cicli biogeochimici, i sistemi di comunicazione batterica, i meccanismi di virulenza e le strategie di adattamento, sia ambiti innovativi, come le tecnologie omiche avanzate, le reti regolative complesse quali il quorum sensing, la formazione di biofilm, i meccanismi di comunicazione intercellulare, lo studio del microbiota e le applicazioni biotecnologiche nel biorisanamento ambientale.
Il tema degli antibiotici e della resistenza antibiotica è trattato in modo diffuso e approfondito, collegando aspetti molecolari a implicazioni cliniche; inoltre, trovano ampio spazio anche altri temi di interesse per la salute umana, come le interazioni ospite-patogeno e i meccanismi di virulenza.
Le principali novità di questa edizione sono:
• ampliamento della virologia, che occupa un’intera sezione (Parte D - Eredità infettiva: i virus)
• trattazione più organica di genomica, metabolomica, biologia dei sistemi
• più attenzione per la microbiologia ambientale, con un capitolo interamente nuovo (Capitolo 19 - Microbiologia ambientale ed ecologia microbica)
• aggiornamento di sistematica e filogenesi in seguito alle recenti scoperte e alle nuove indicazioni internazionali
Numerose schede di approfondimento sono dedicate agli antibiotici, alla sistematica e ad altri argomenti di rilievo. Nel sito del libro sono inoltre disponibili altri approfondimenti, test interattivi e il Laboratorio interattivo
Autori e autrici
Pietro Alifano, Loredana Baccigalupi, Marco Bazzicalupo, Maria Lina Bernardini, Gianni Dehò, Giovanna Felis, Andrea Franzetti, Enrica Galli, Giorgio Gribaudo, Paolo Landini, Giovanna Lucchini, Gabriele Andrea Lugli, Orietta Massidda, Alessio Mengoni, Marco Rinaldo Oggioni, Luciano Paolozzi, Alessandra Polissi, Anna Maria Puglia, Paola Quatrini, Ezio Ricca, Anna Maria Sanangelantoni, Margherita Sosio, Stefania Stefani, Francesca Turroni, Marco Ventura, Davide Zannoni